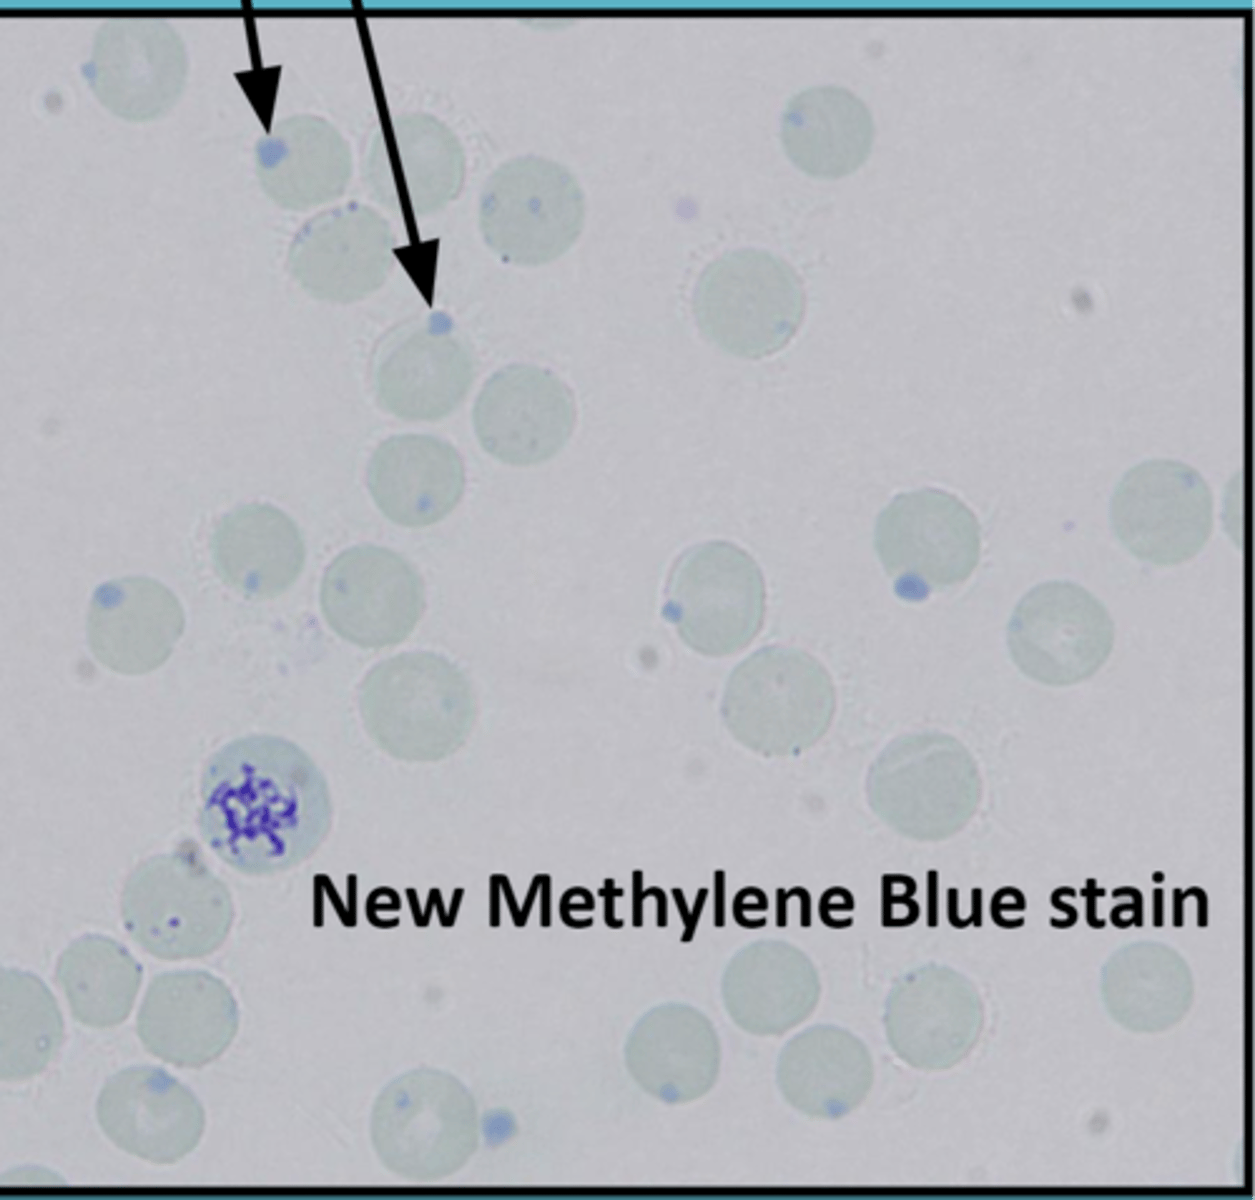
knowt flashcard image
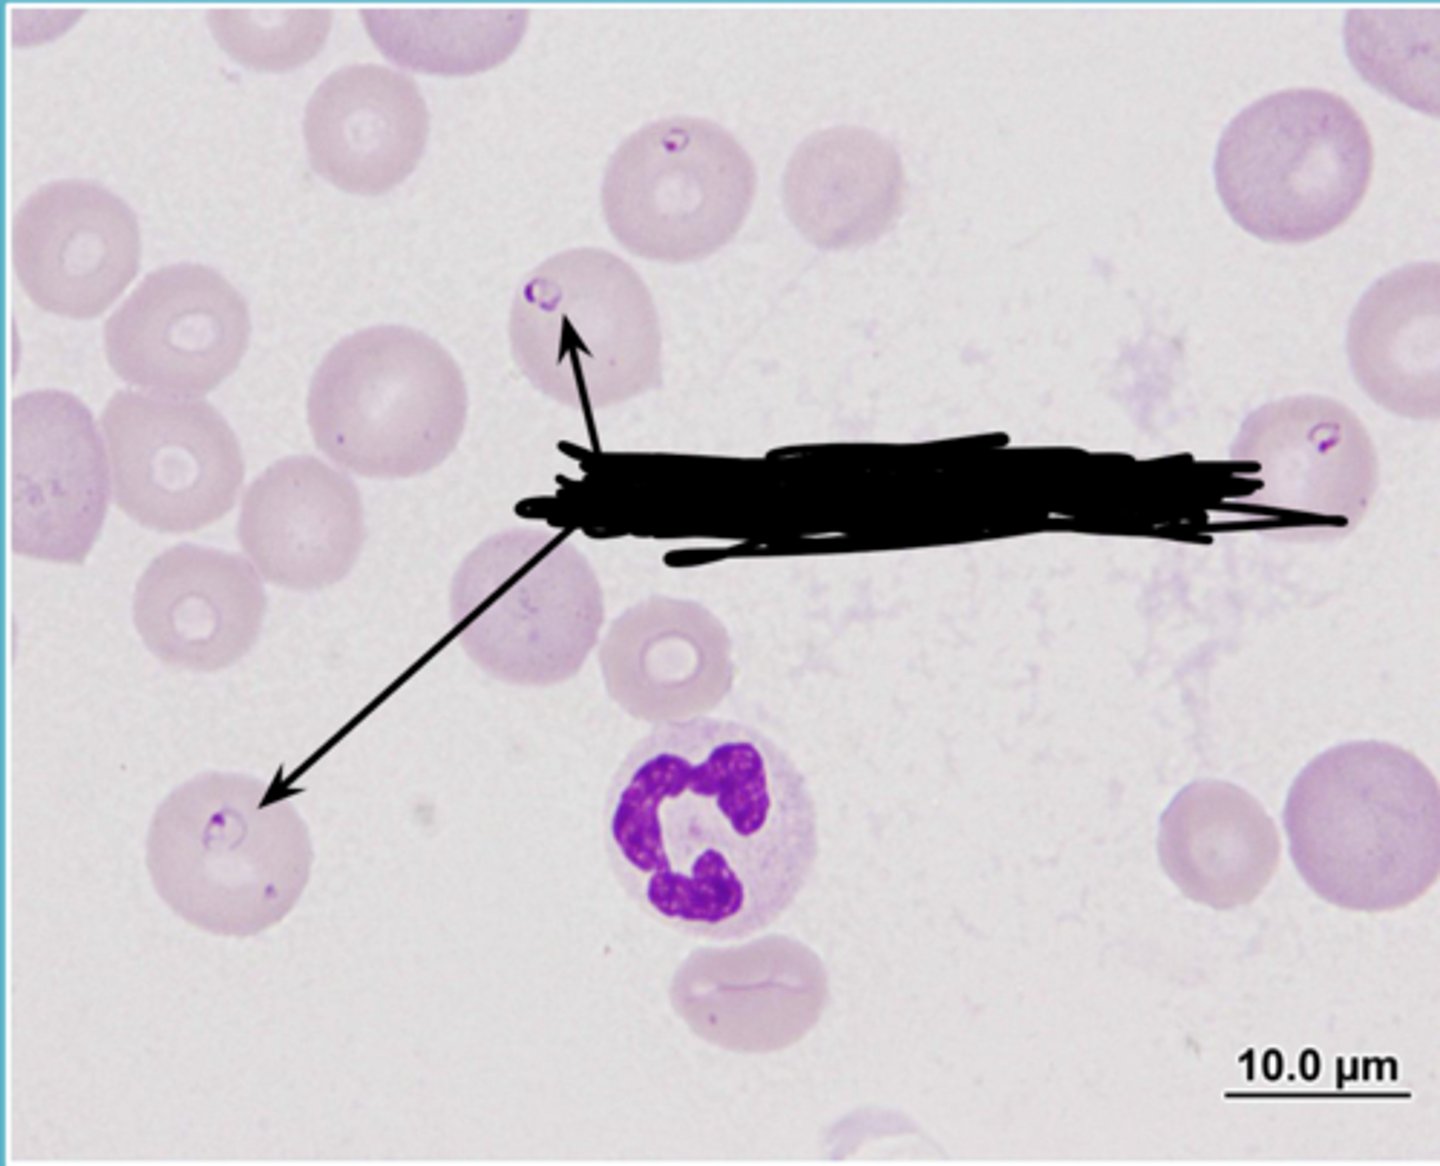
knowt flashcard image
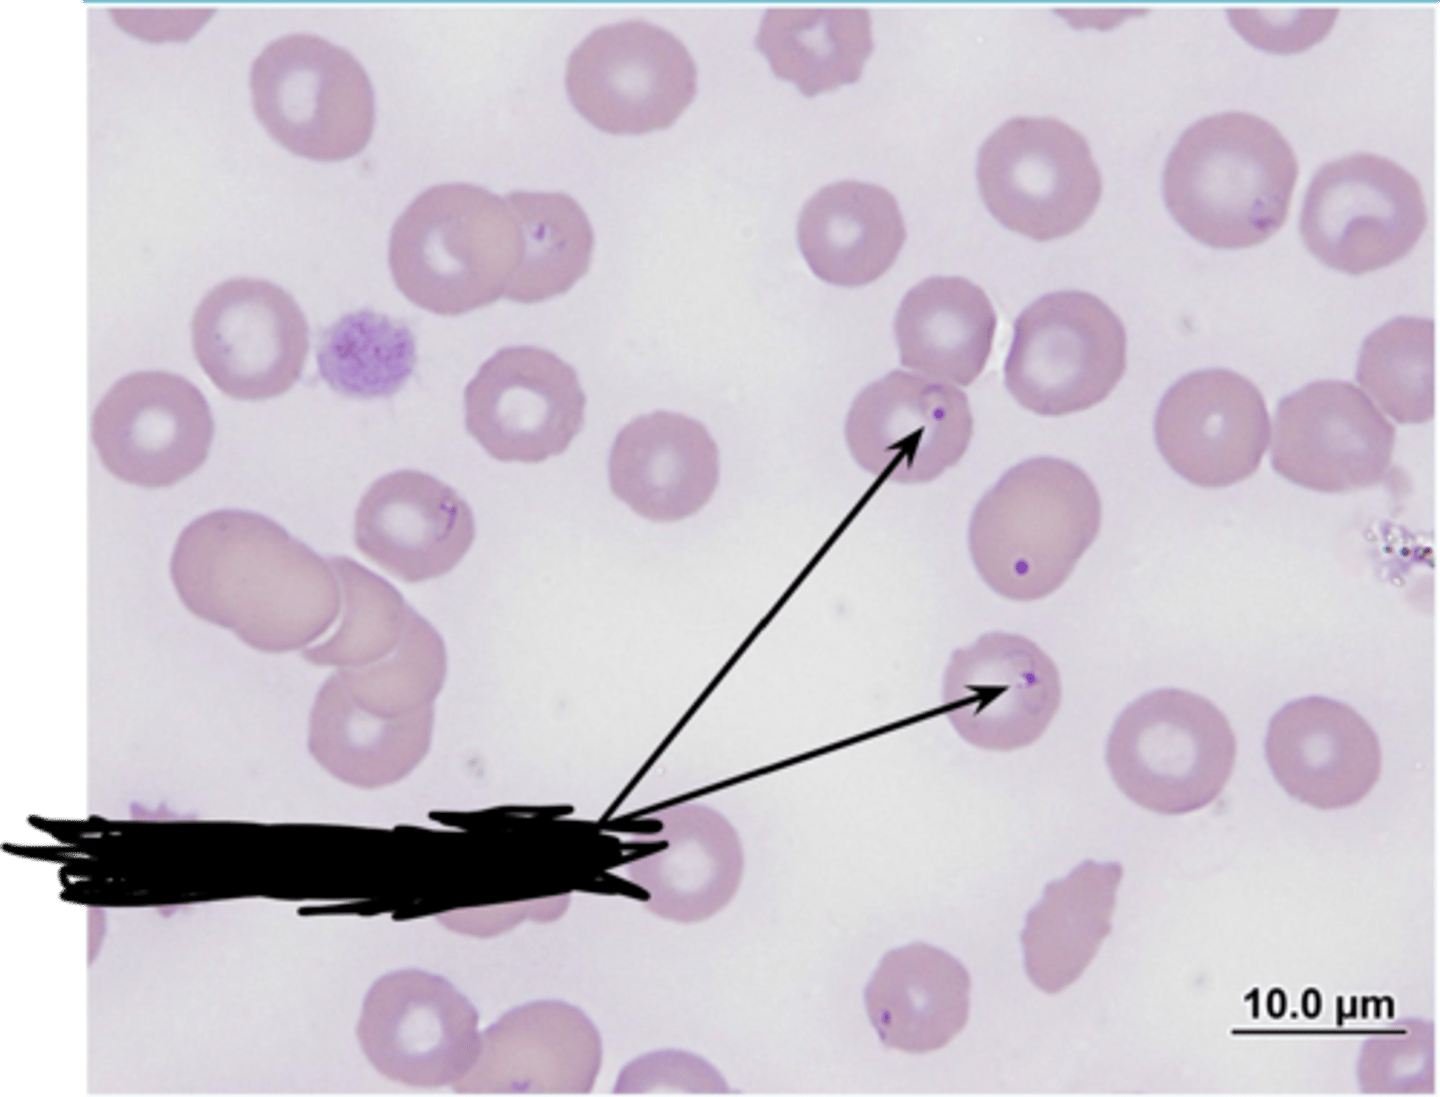
knowt flashcard image
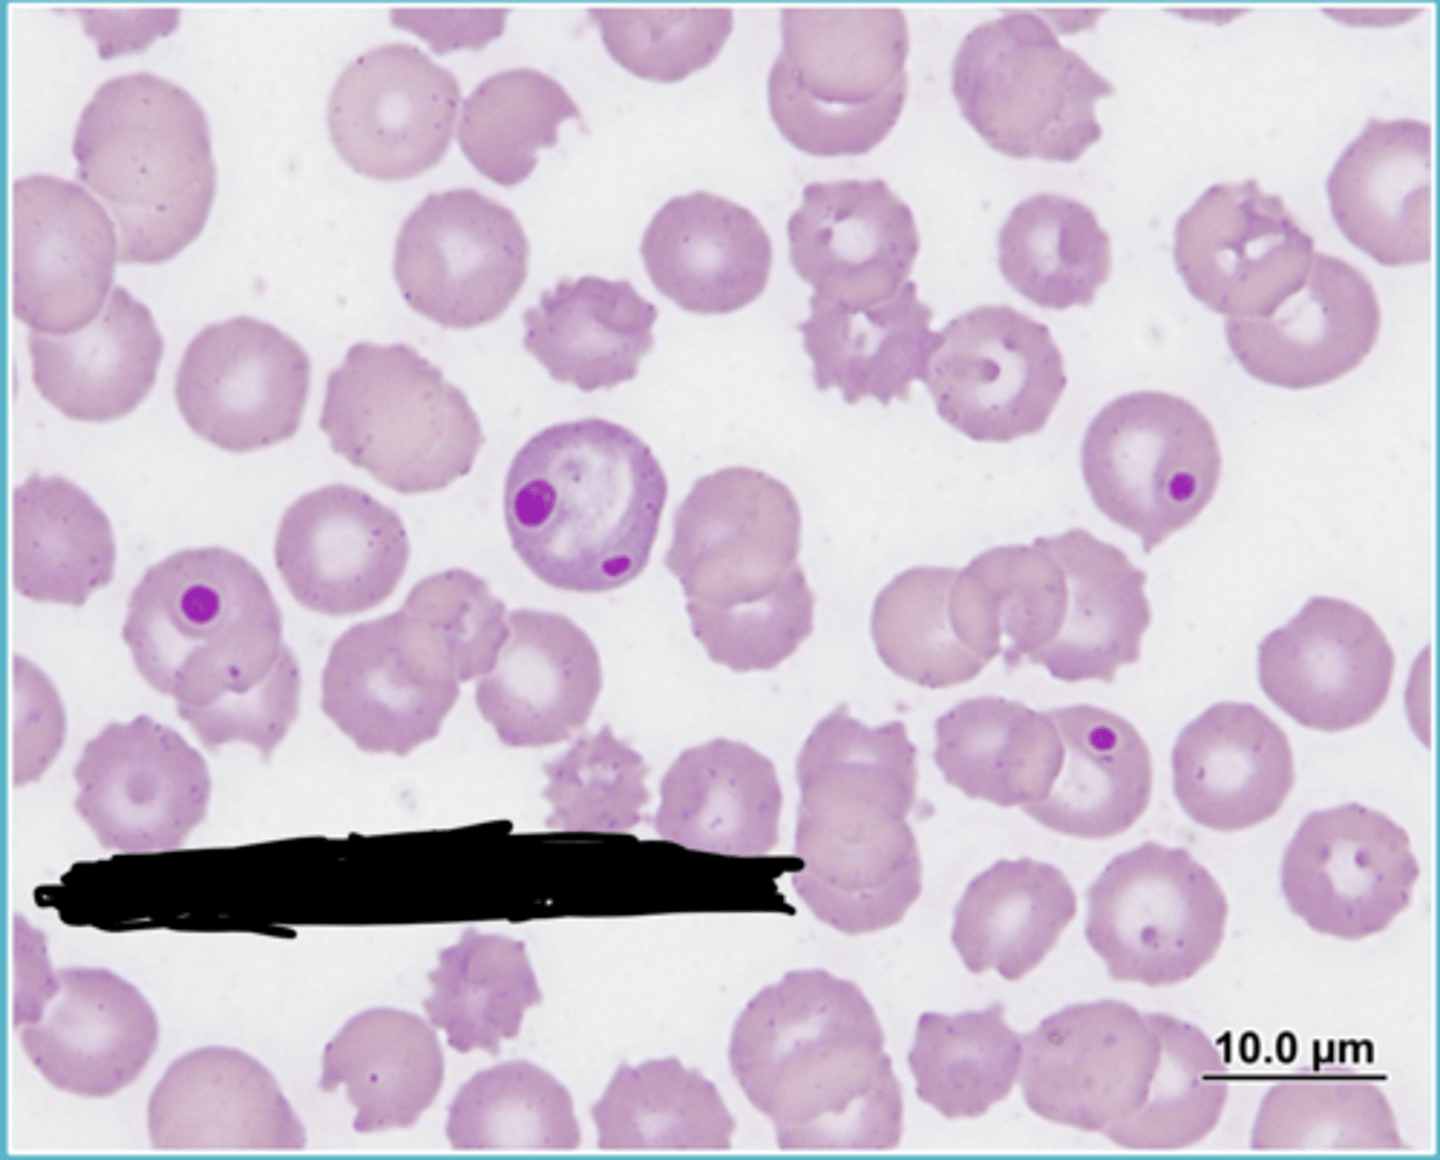
knowt flashcard image
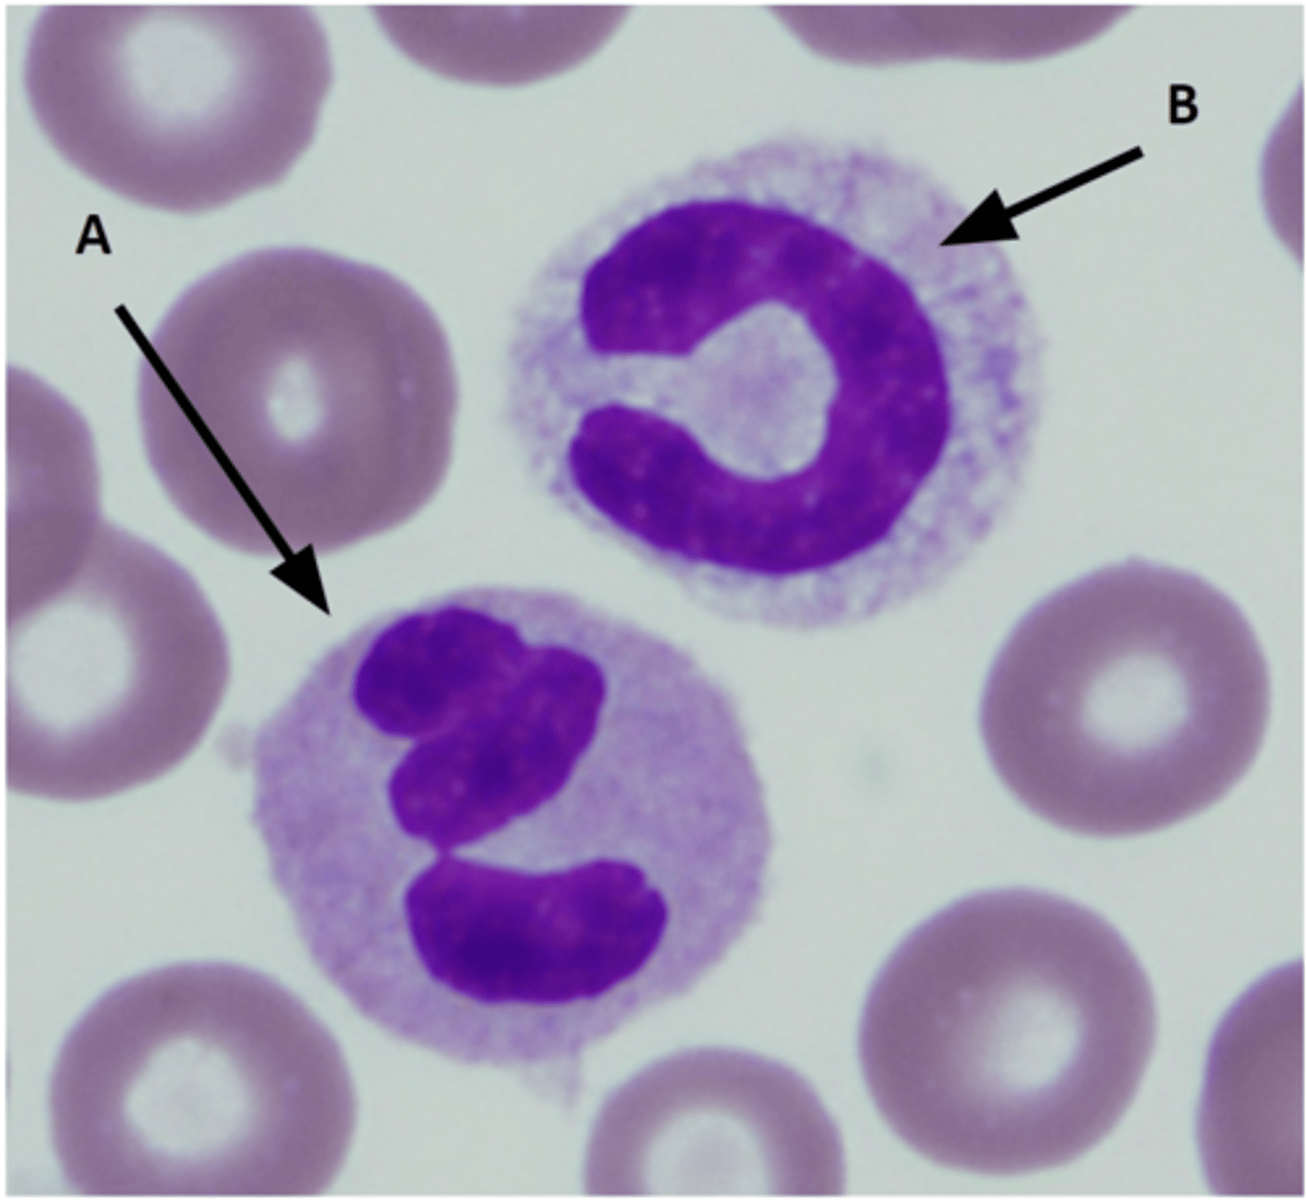
knowt flashcard image
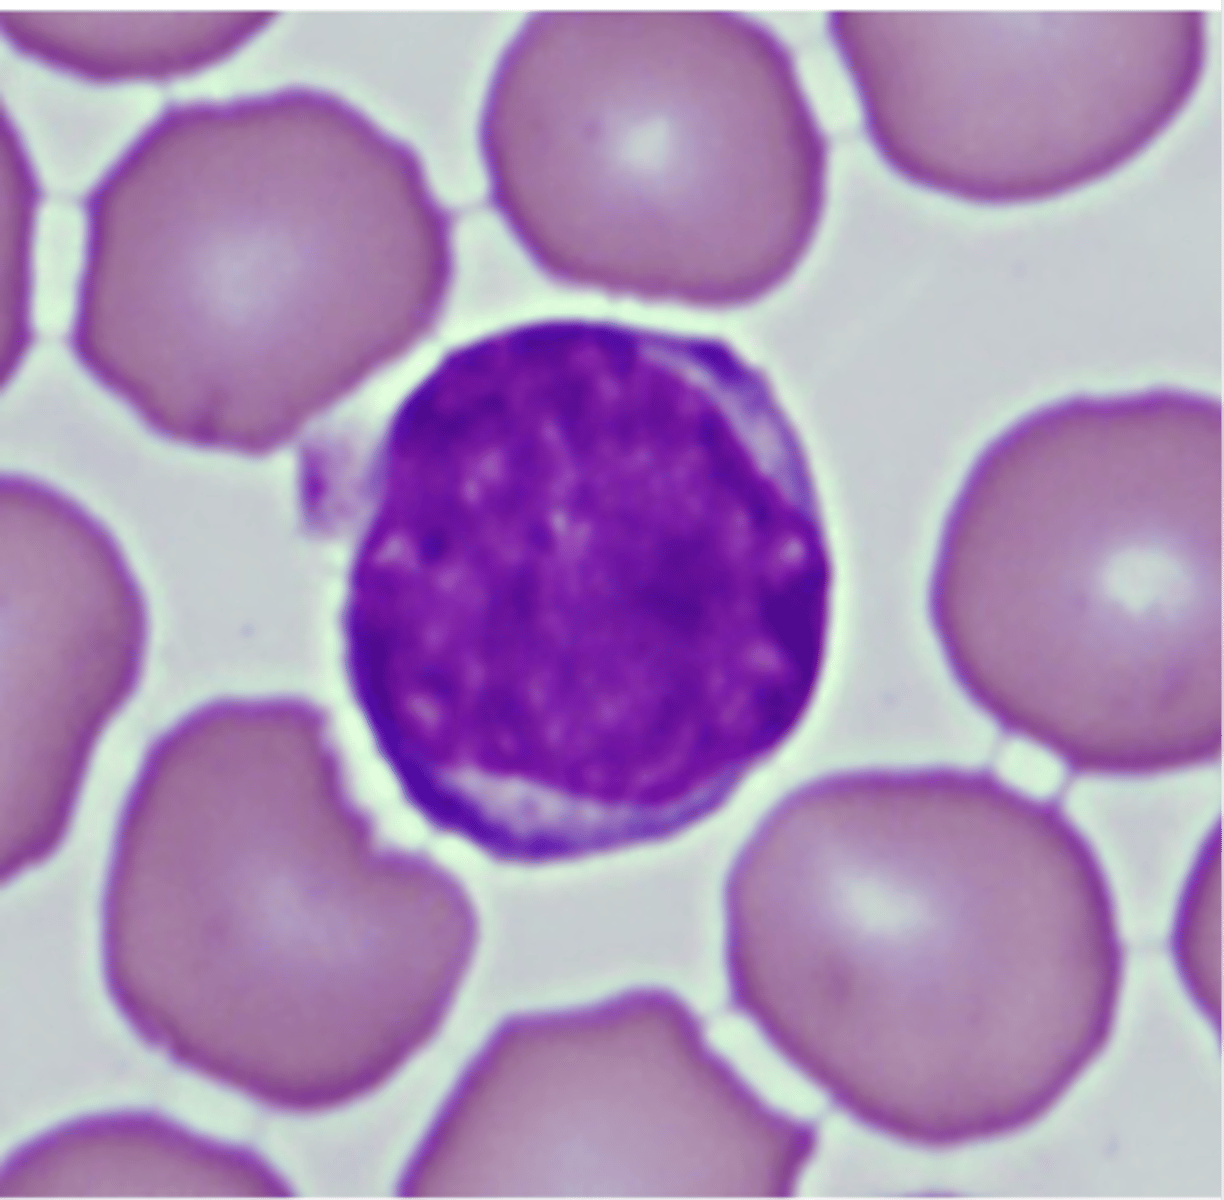
knowt flashcard image
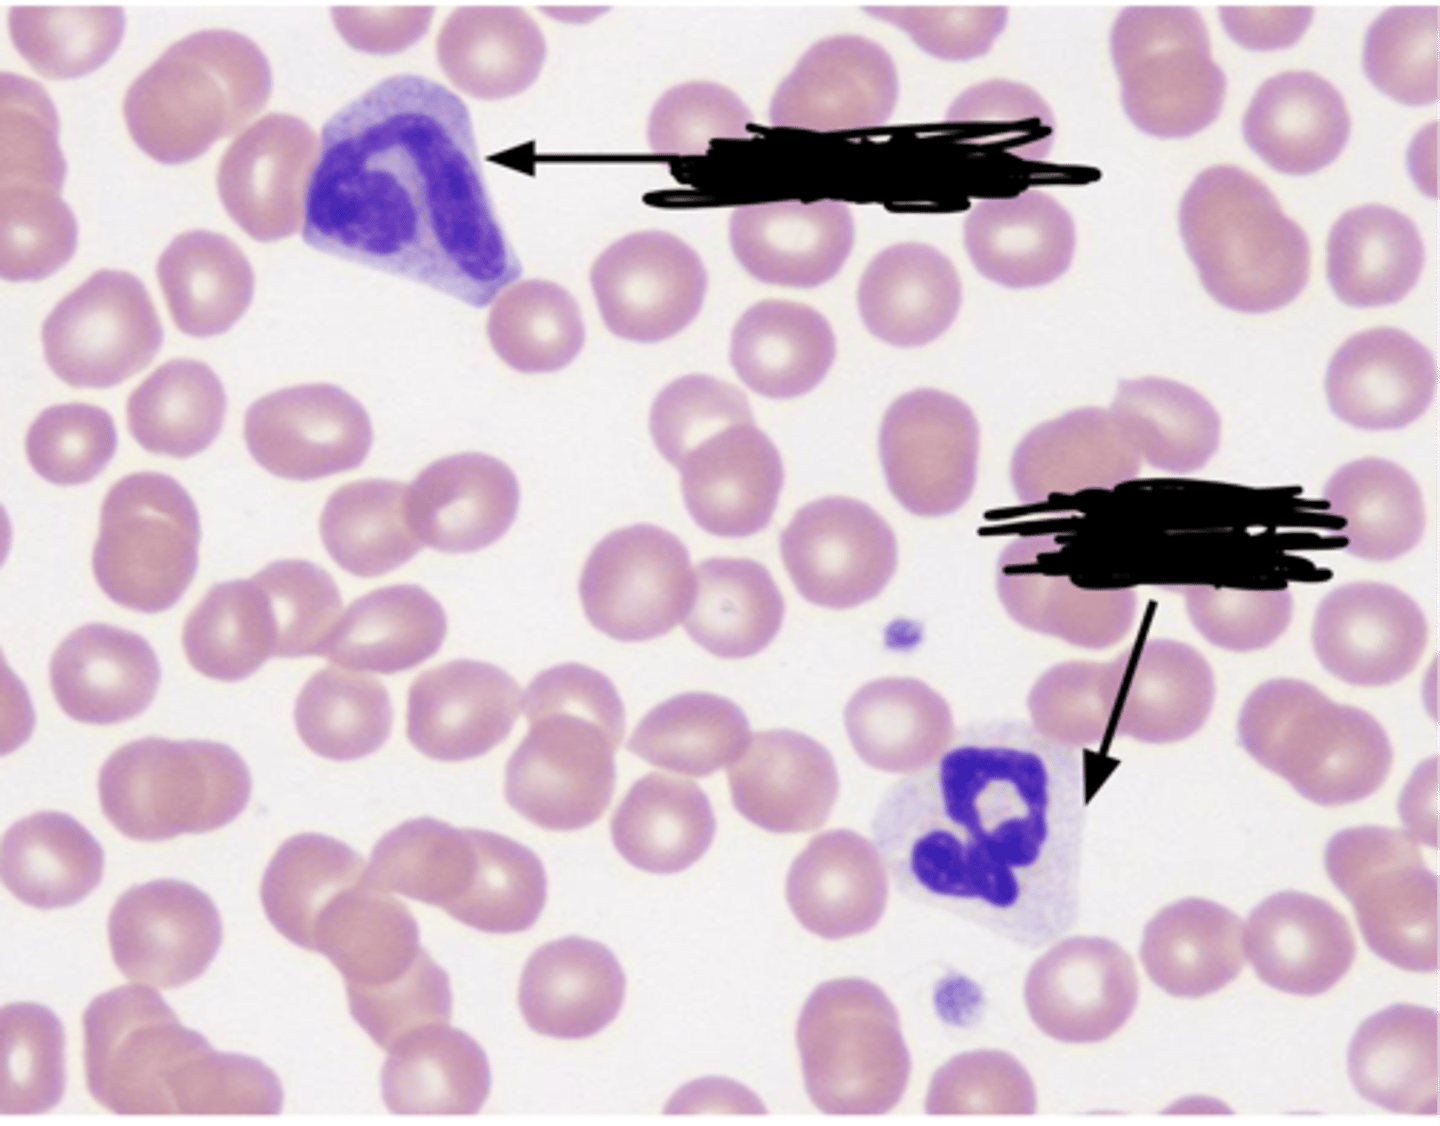
knowt flashcard image
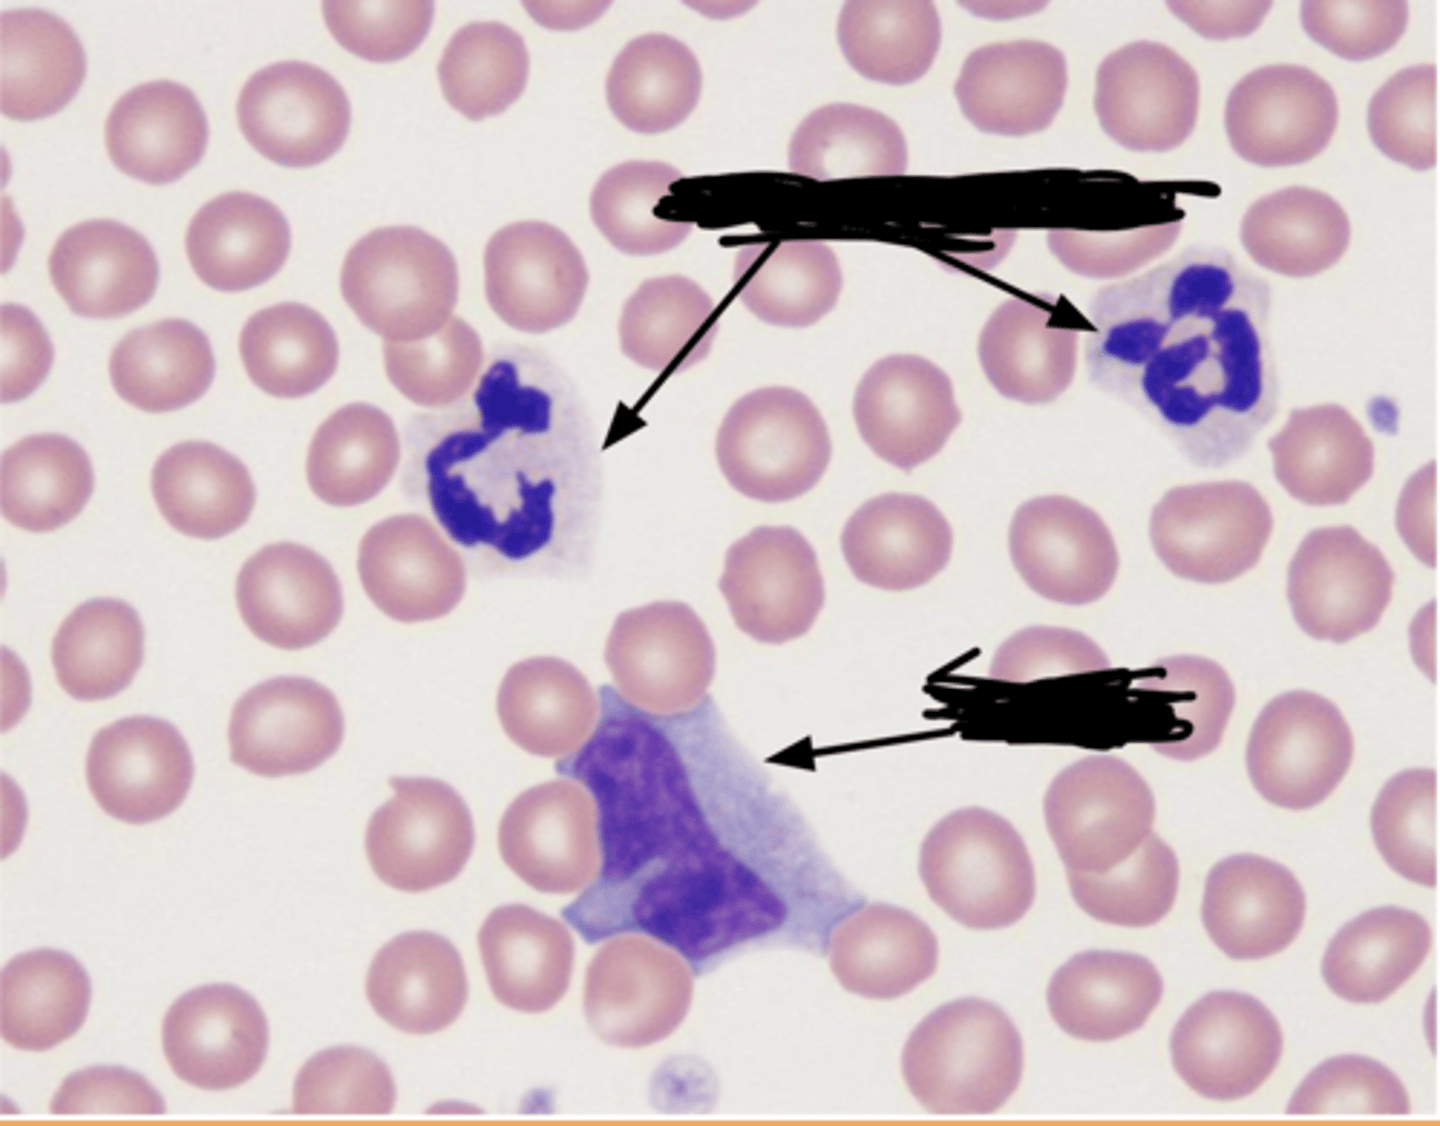
knowt flashcard image
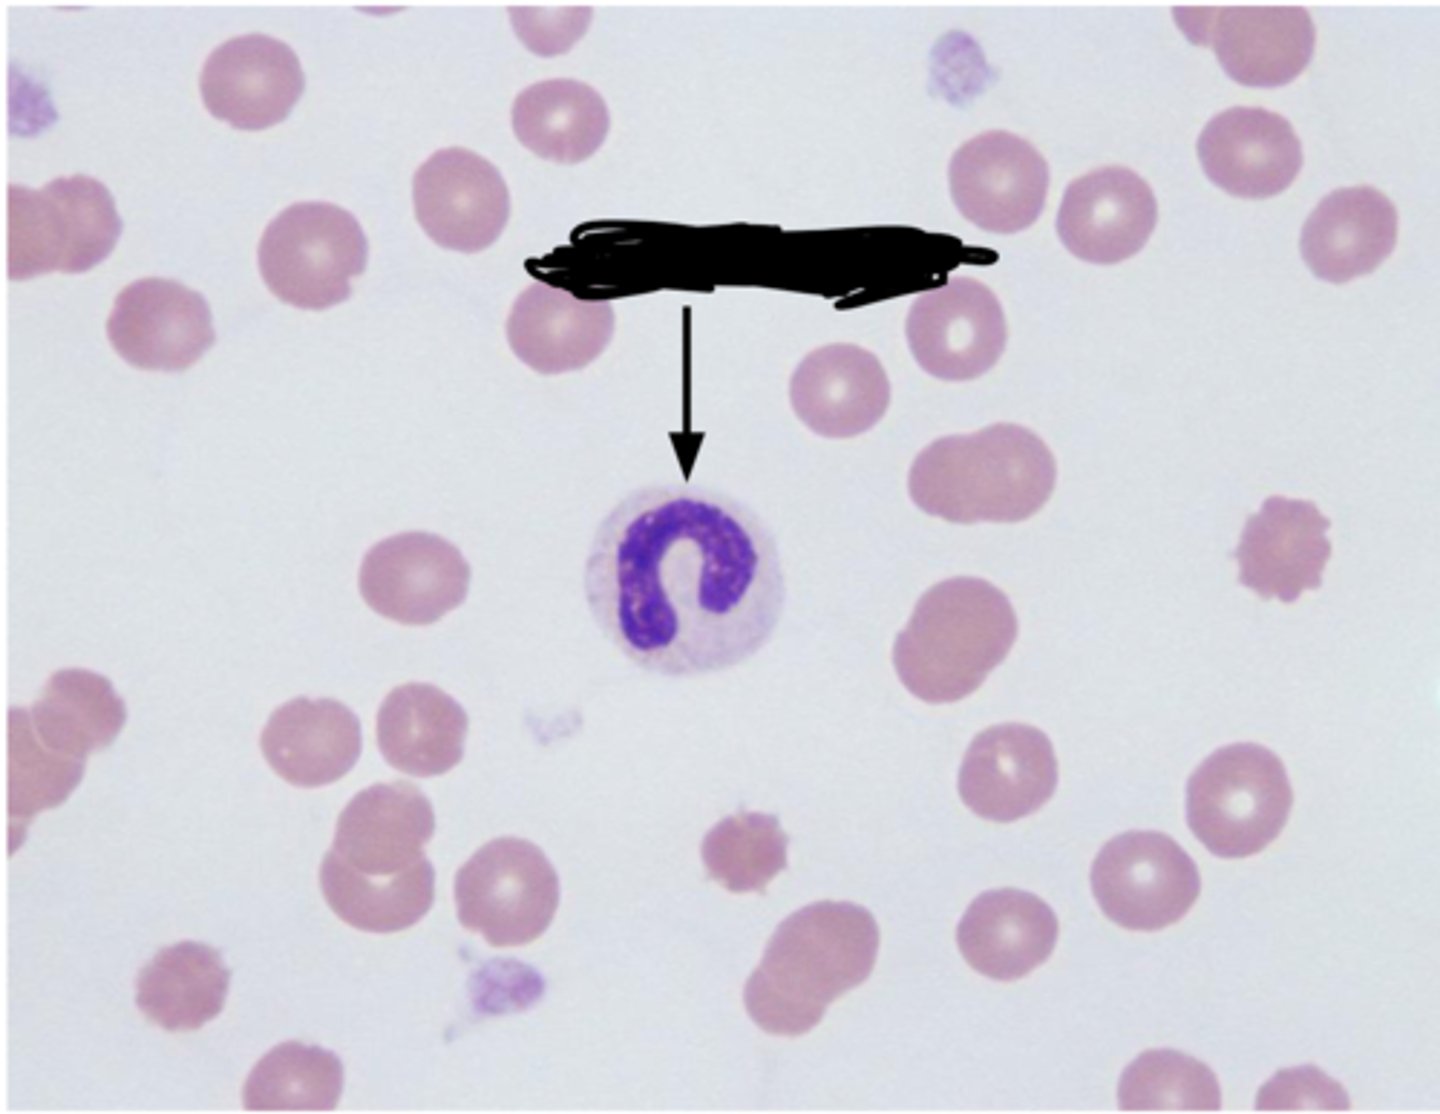
knowt flashcard image
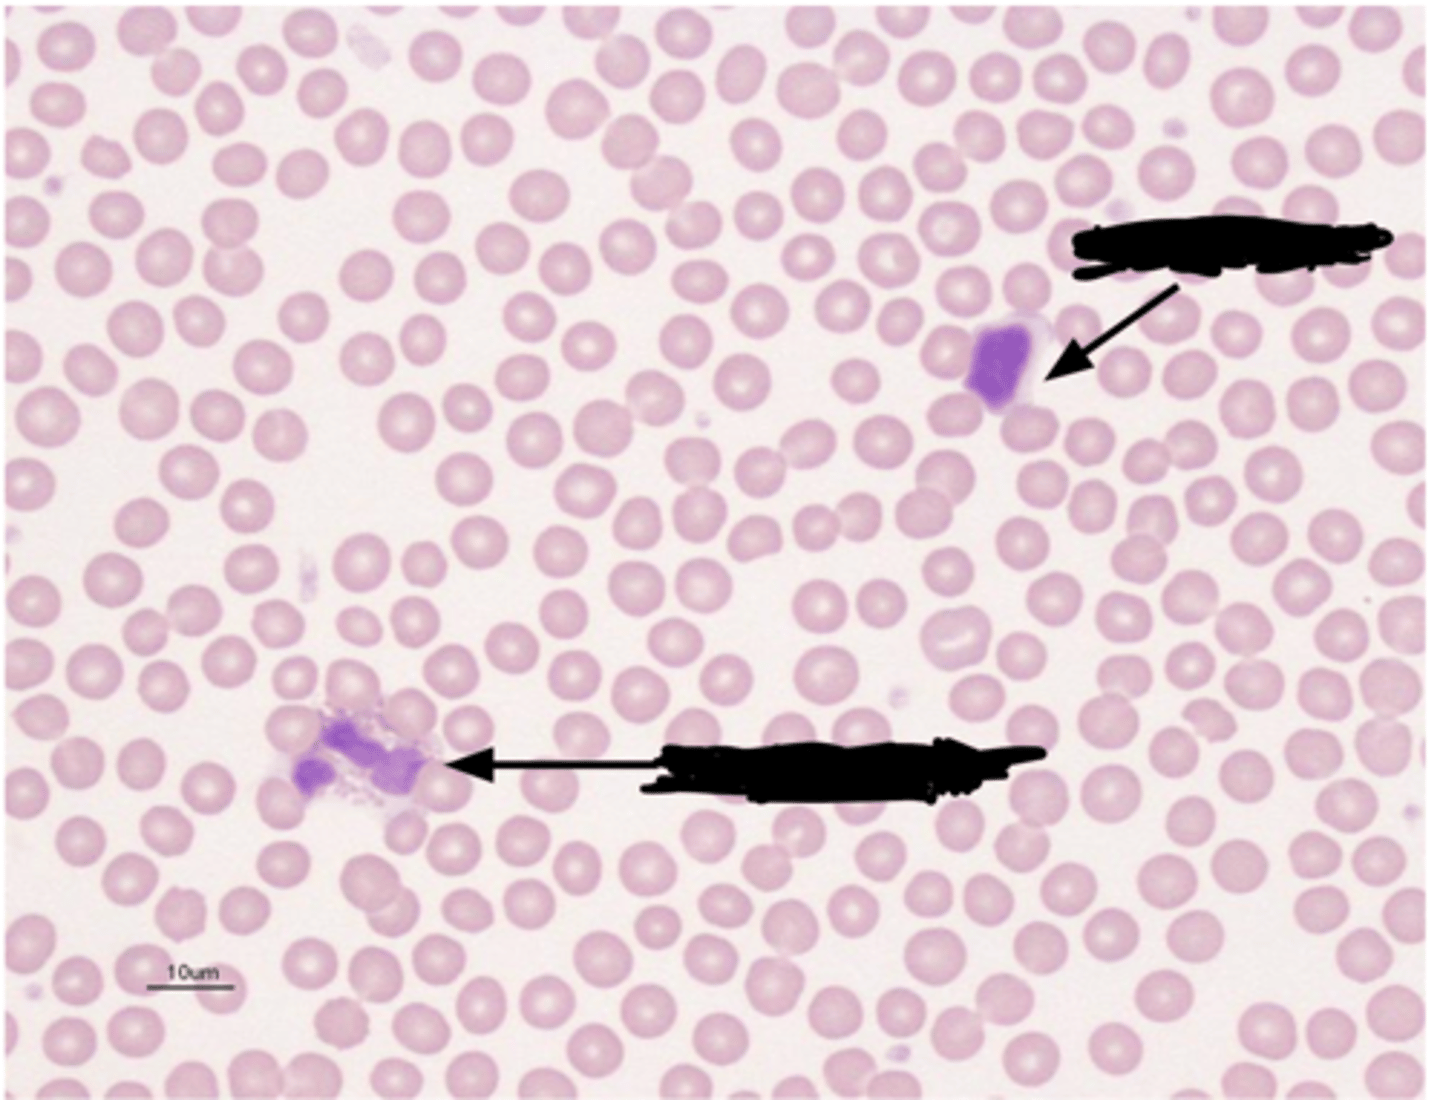
knowt flashcard image
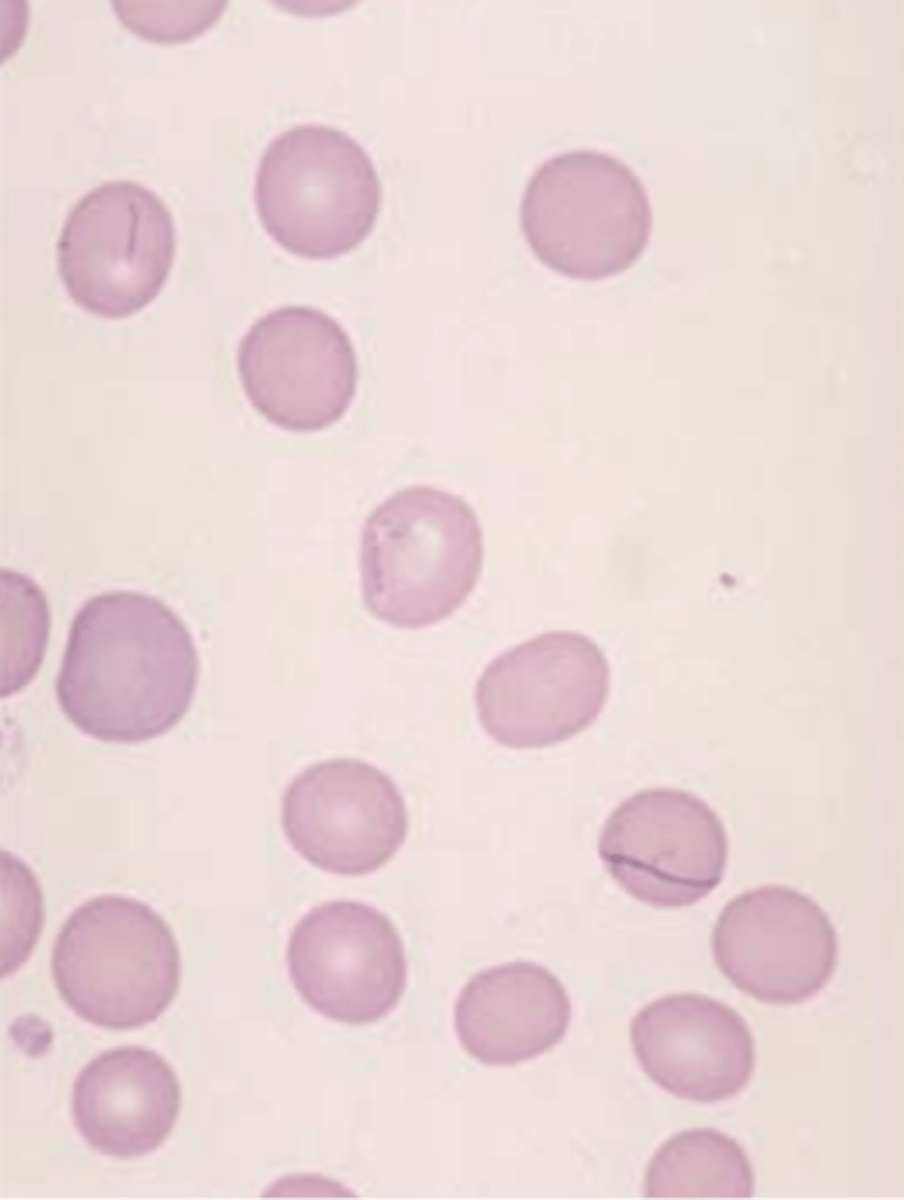
knowt flashcard image
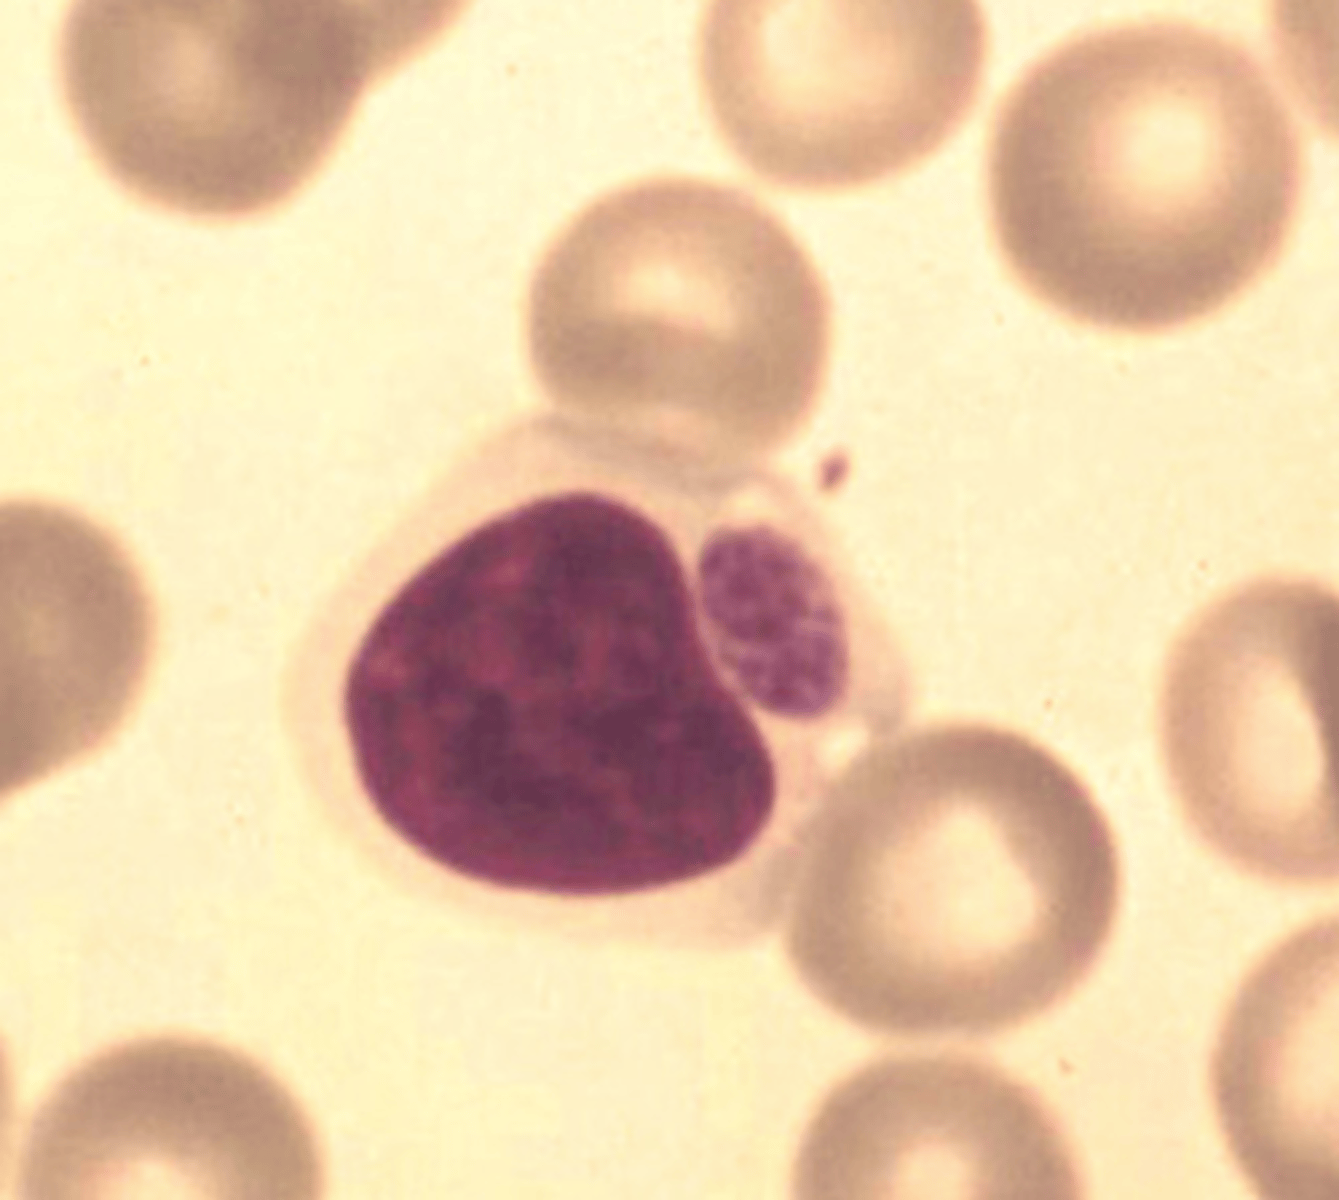
knowt flashcard image
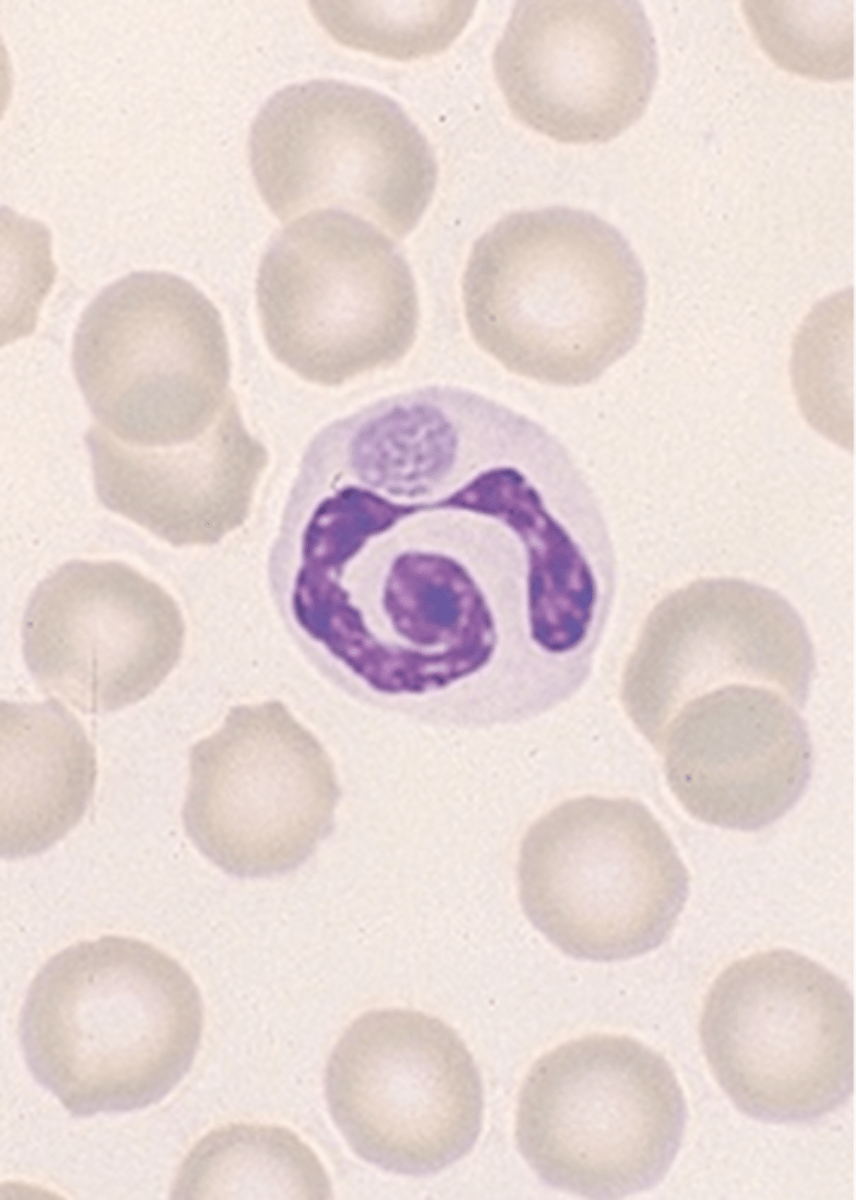
knowt flashcard image
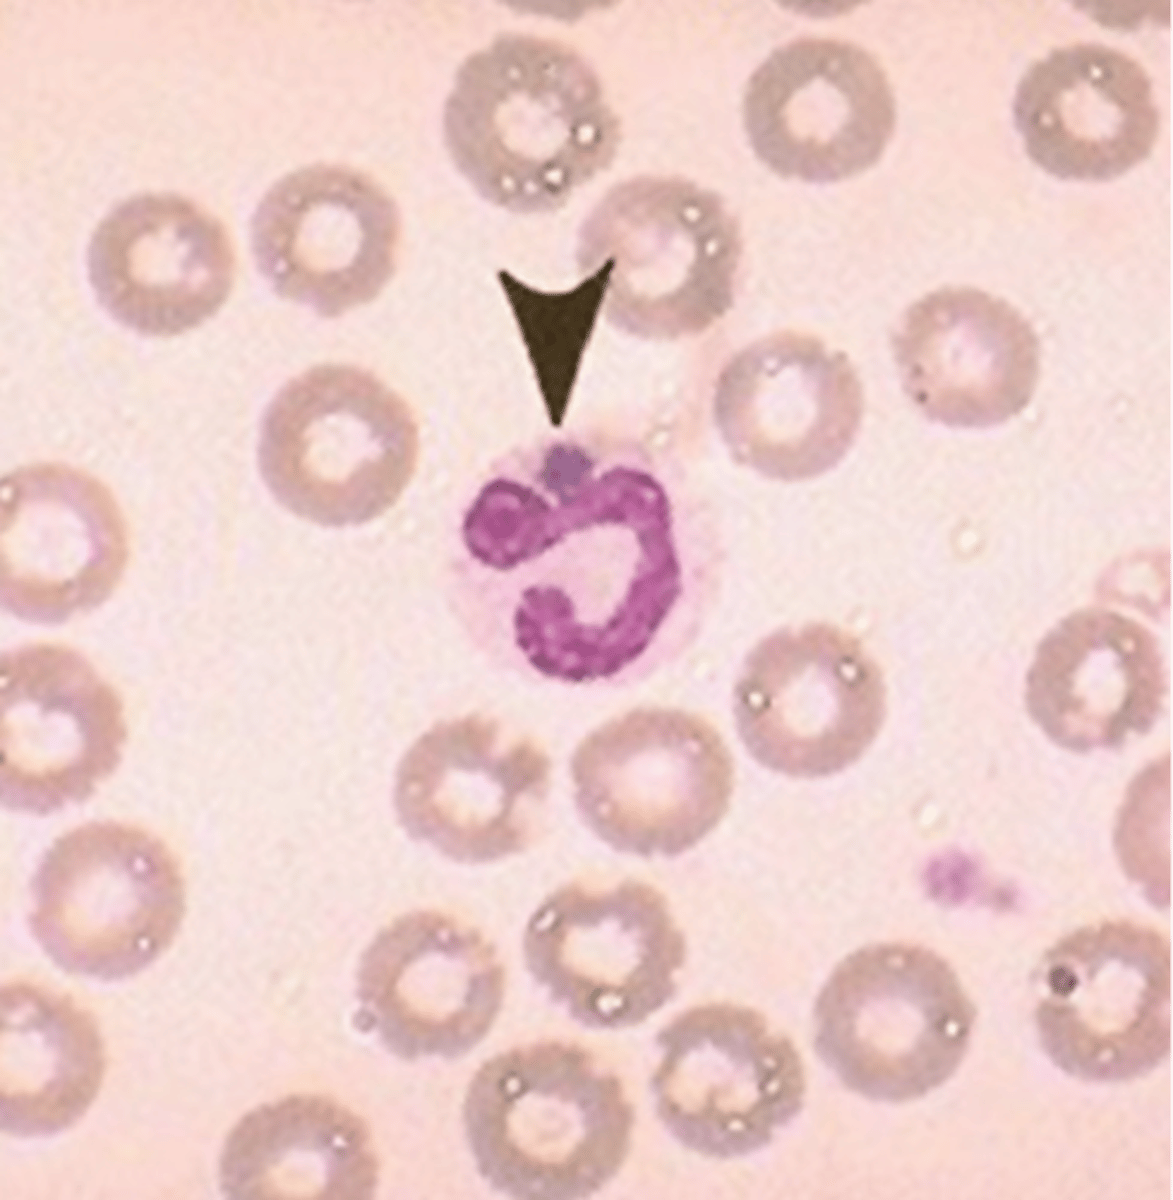
knowt flashcard image
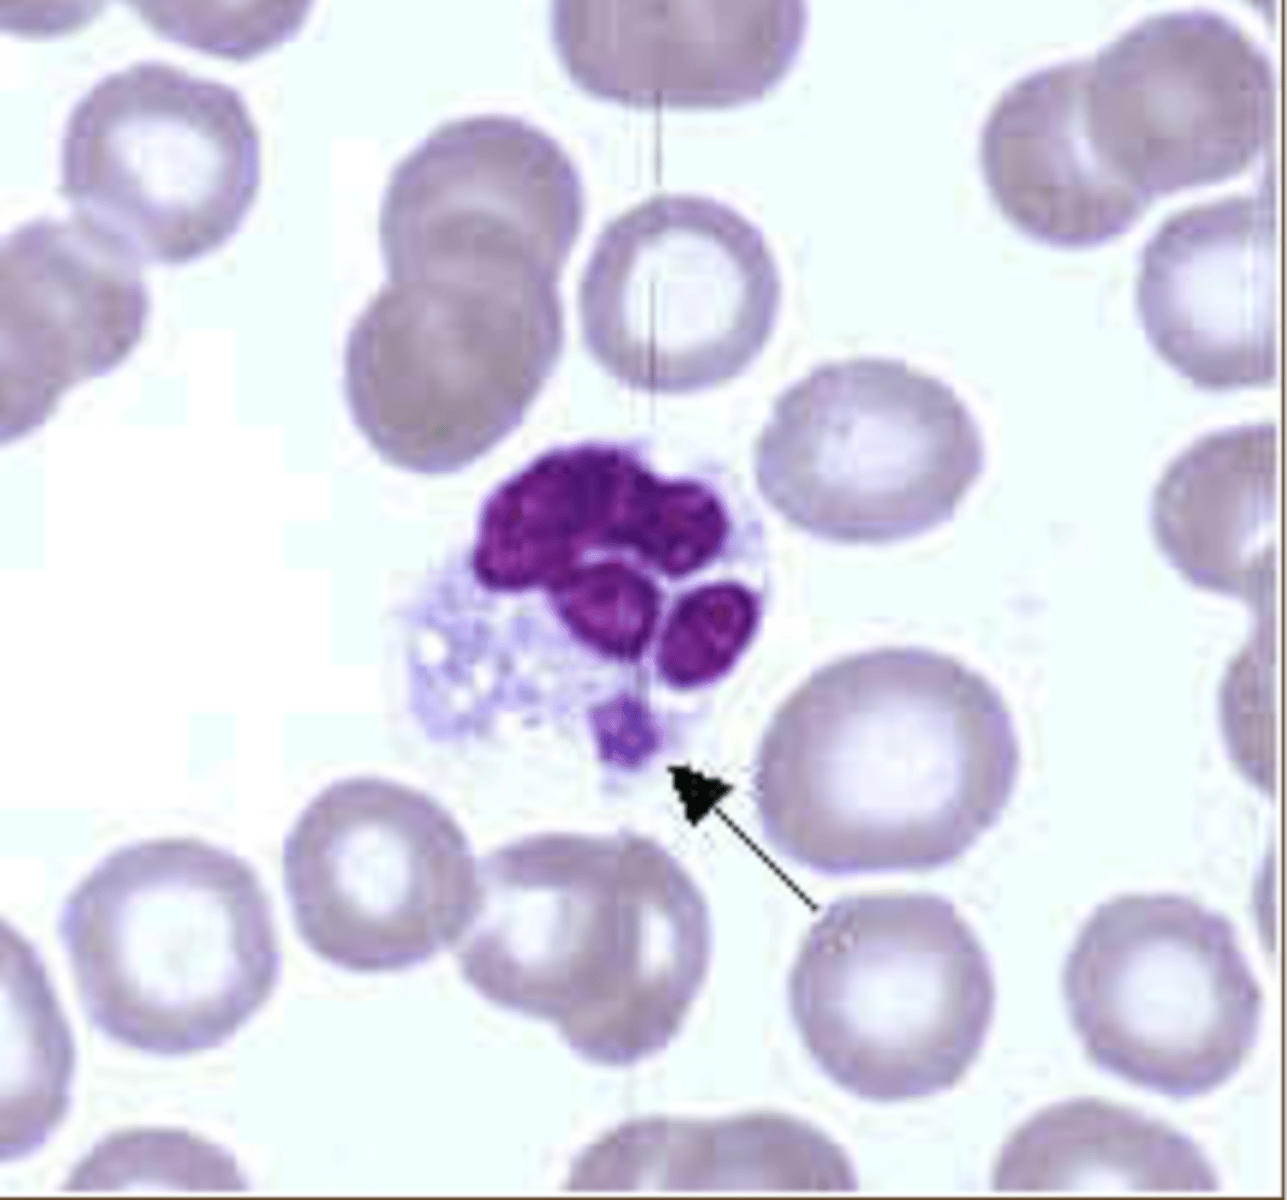
knowt flashcard image
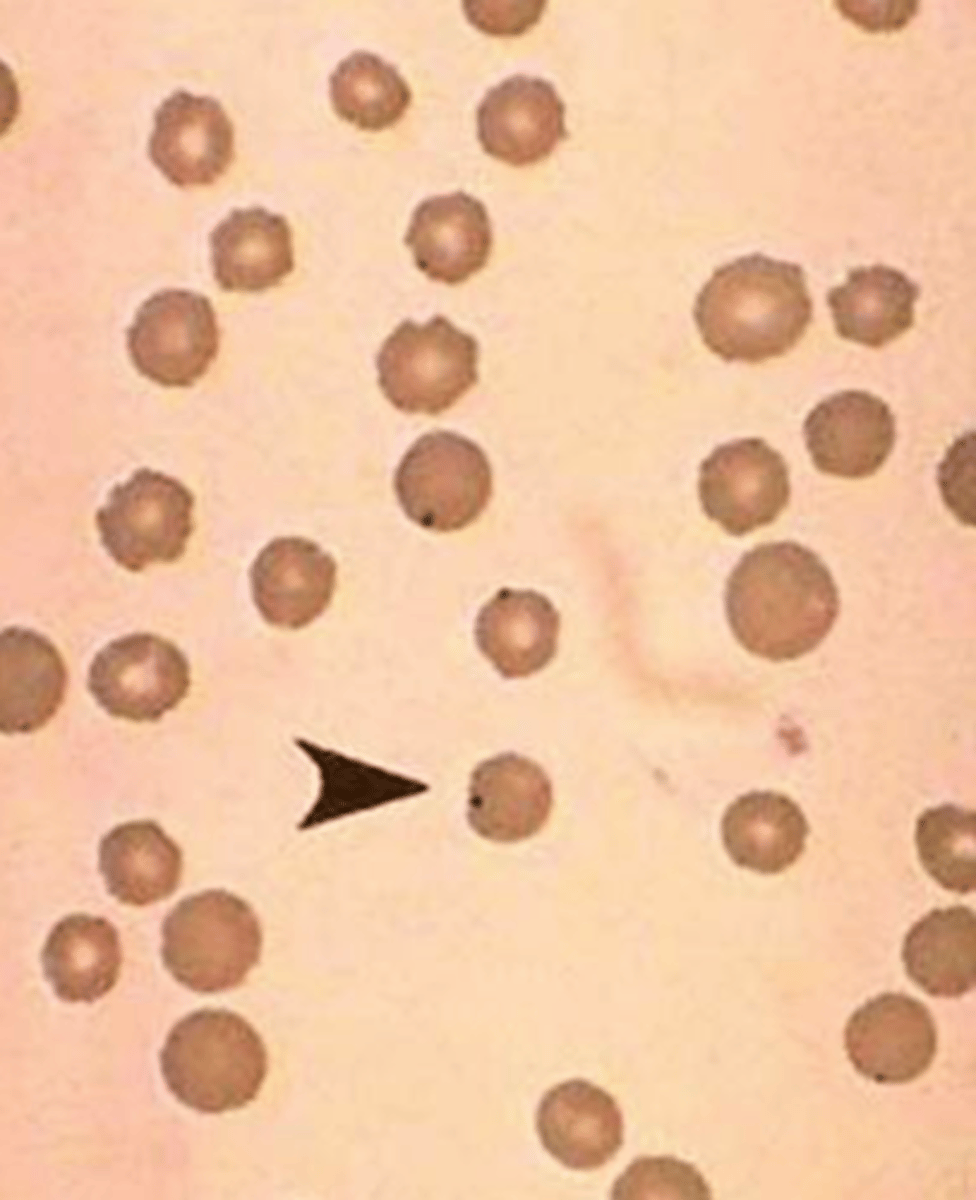
knowt flashcard image
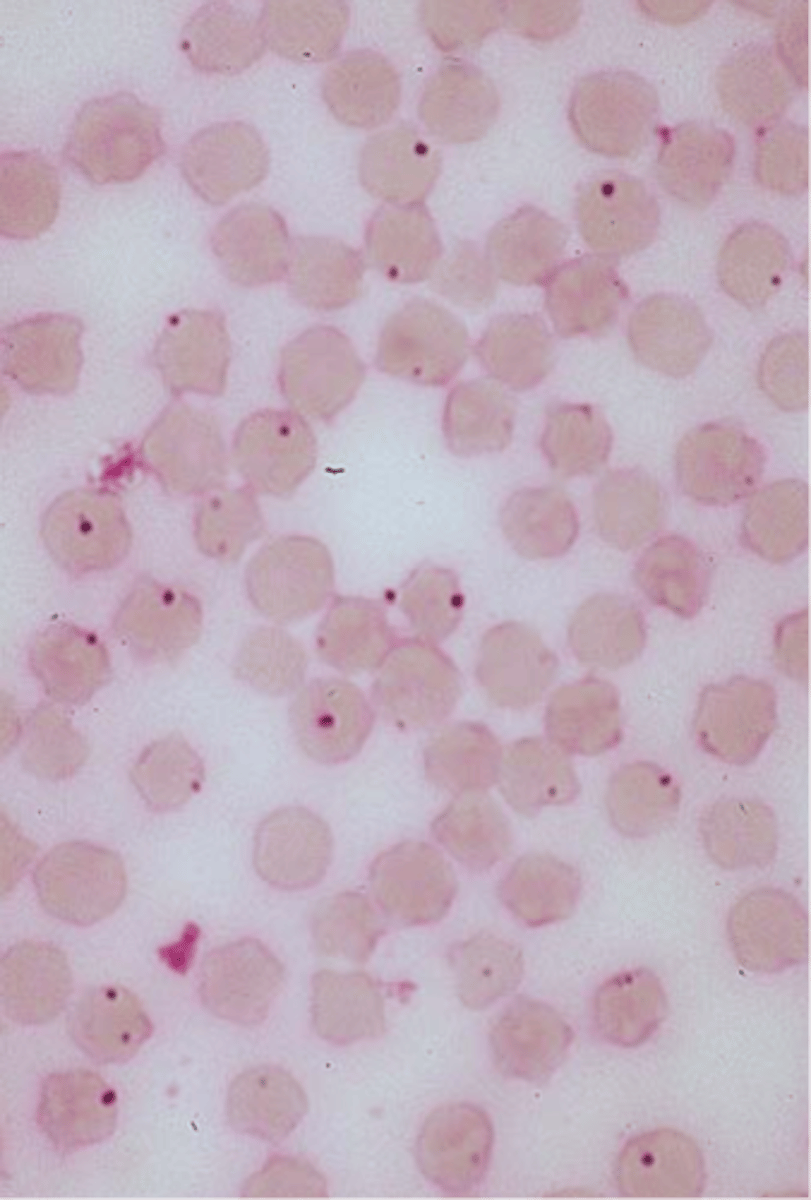
knowt flashcard image
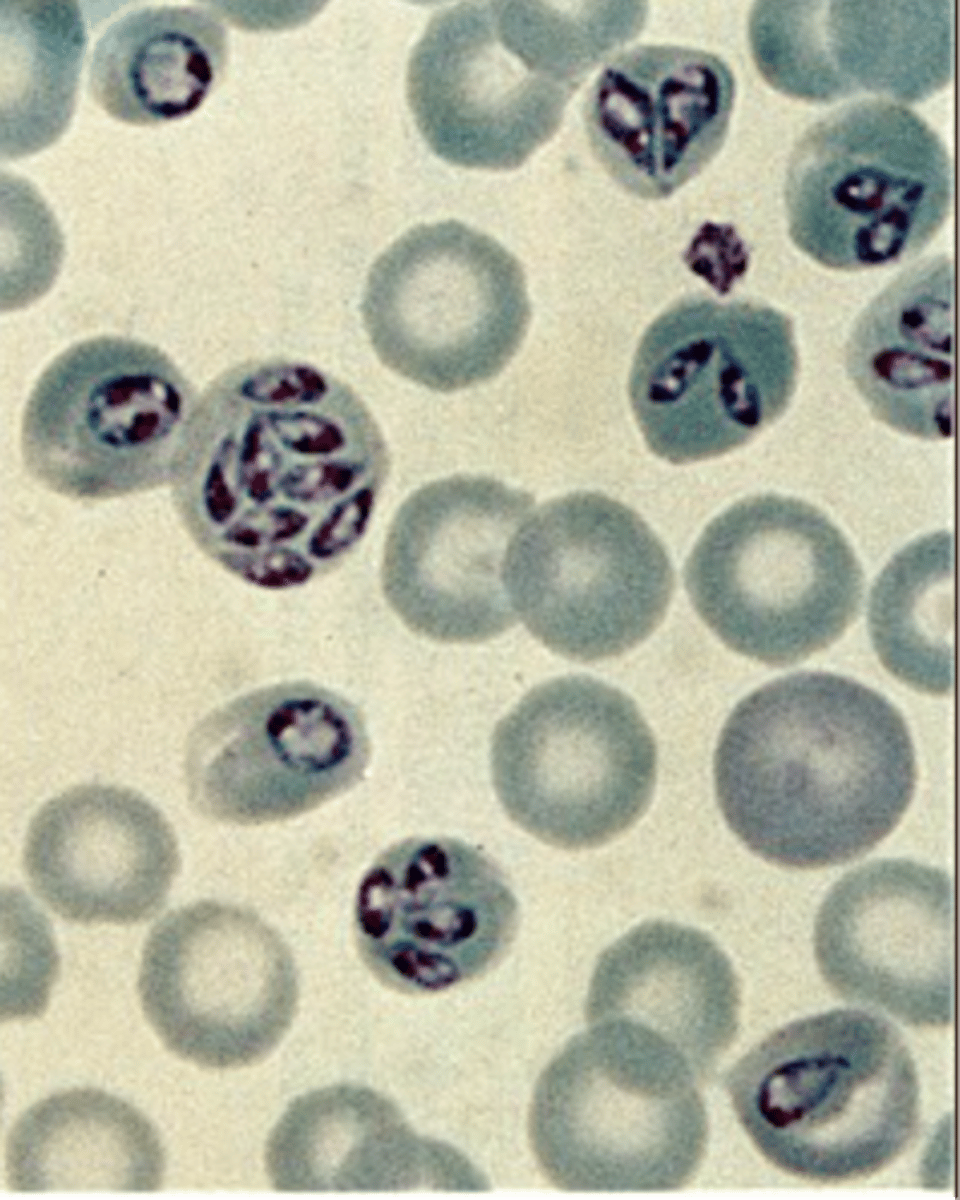
knowt flashcard image
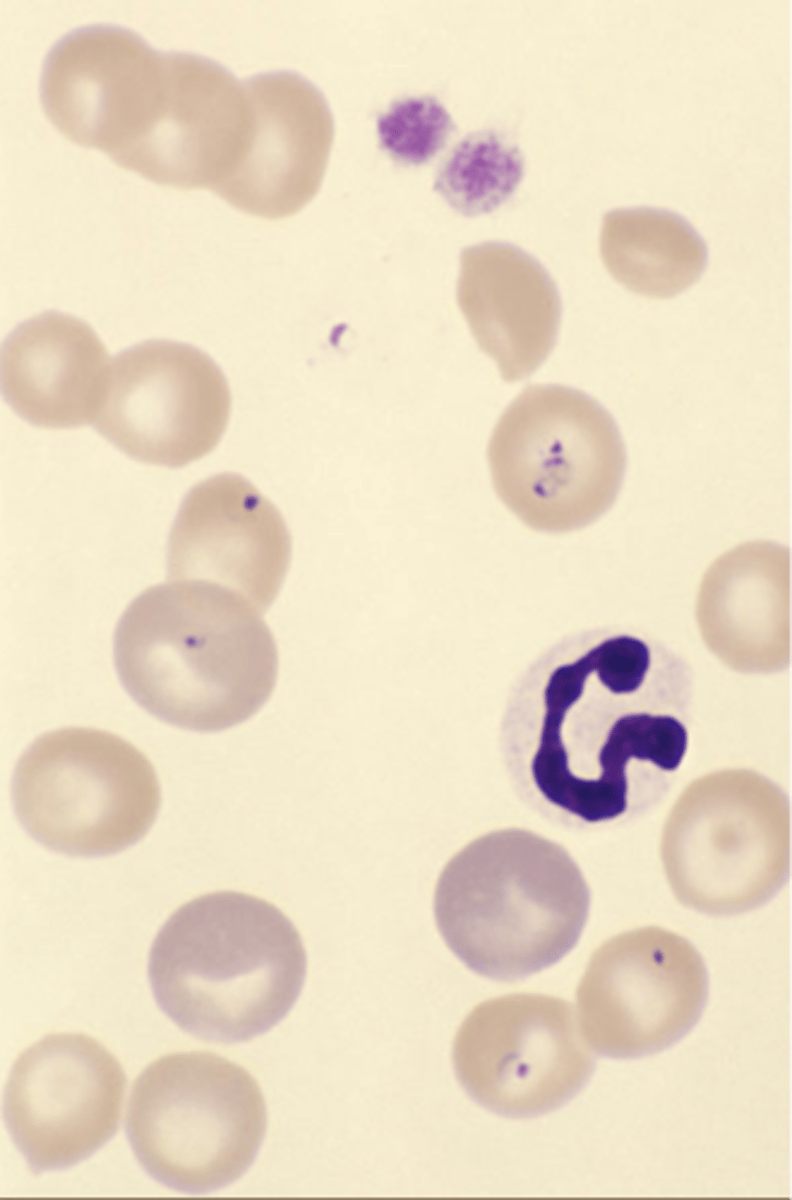
knowt flashcard image
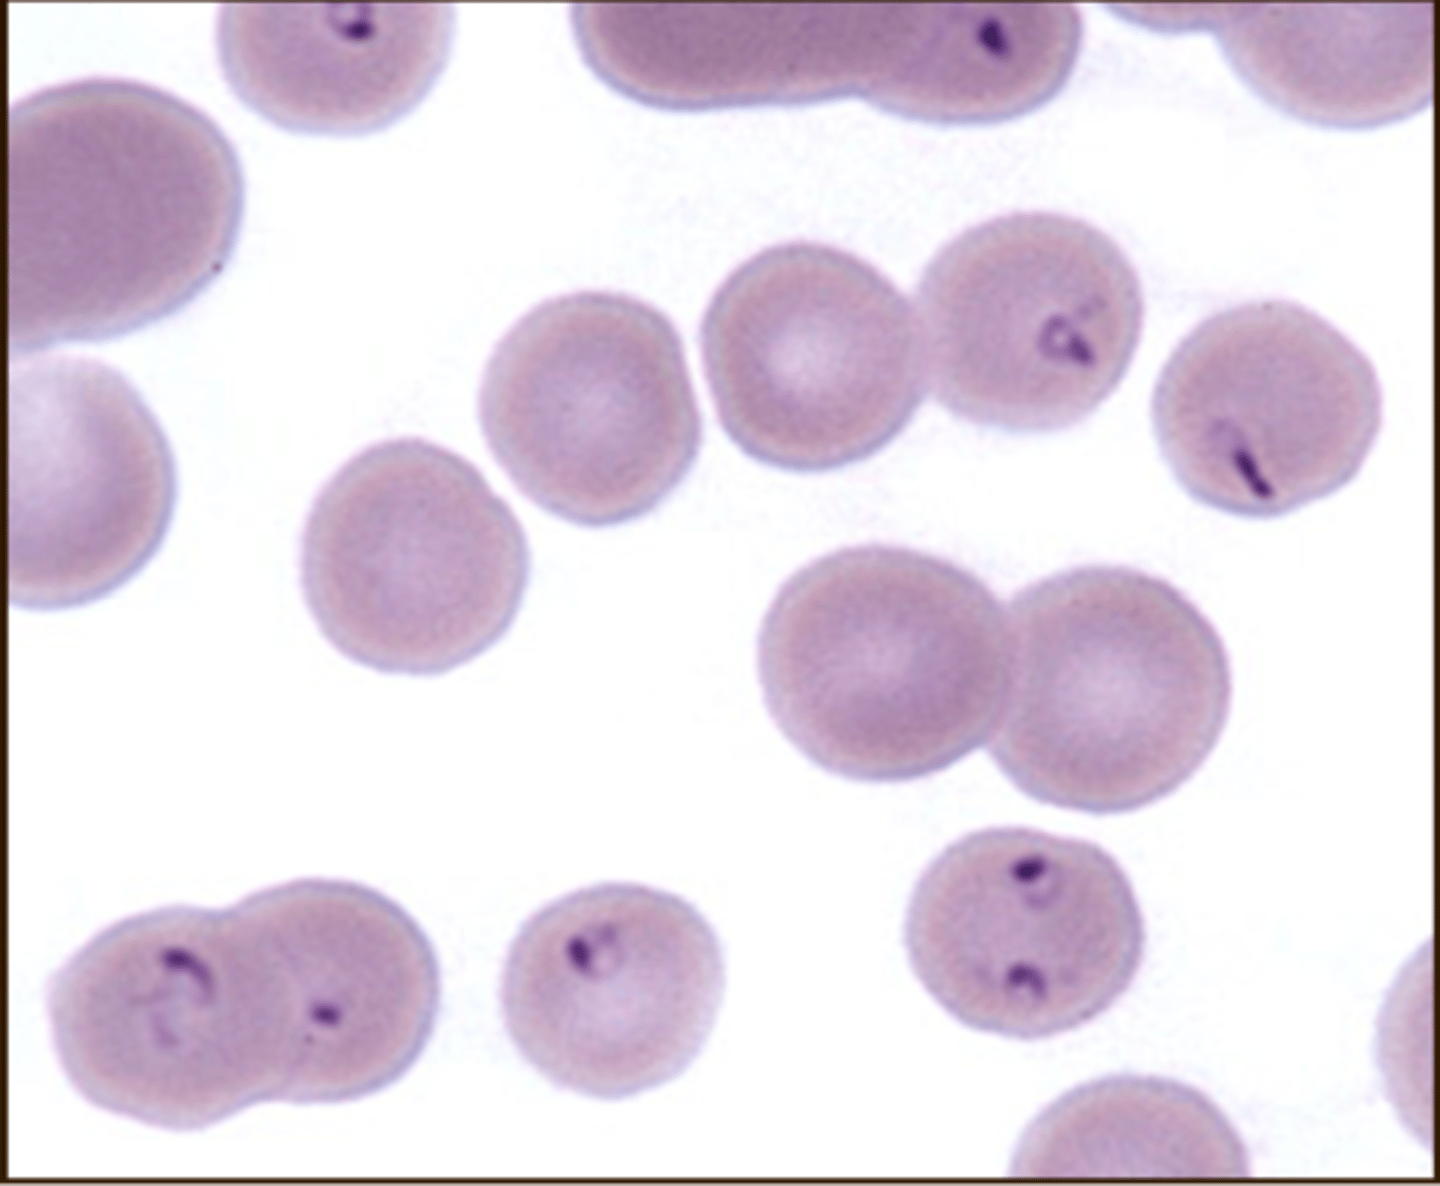
knowt flashcard image
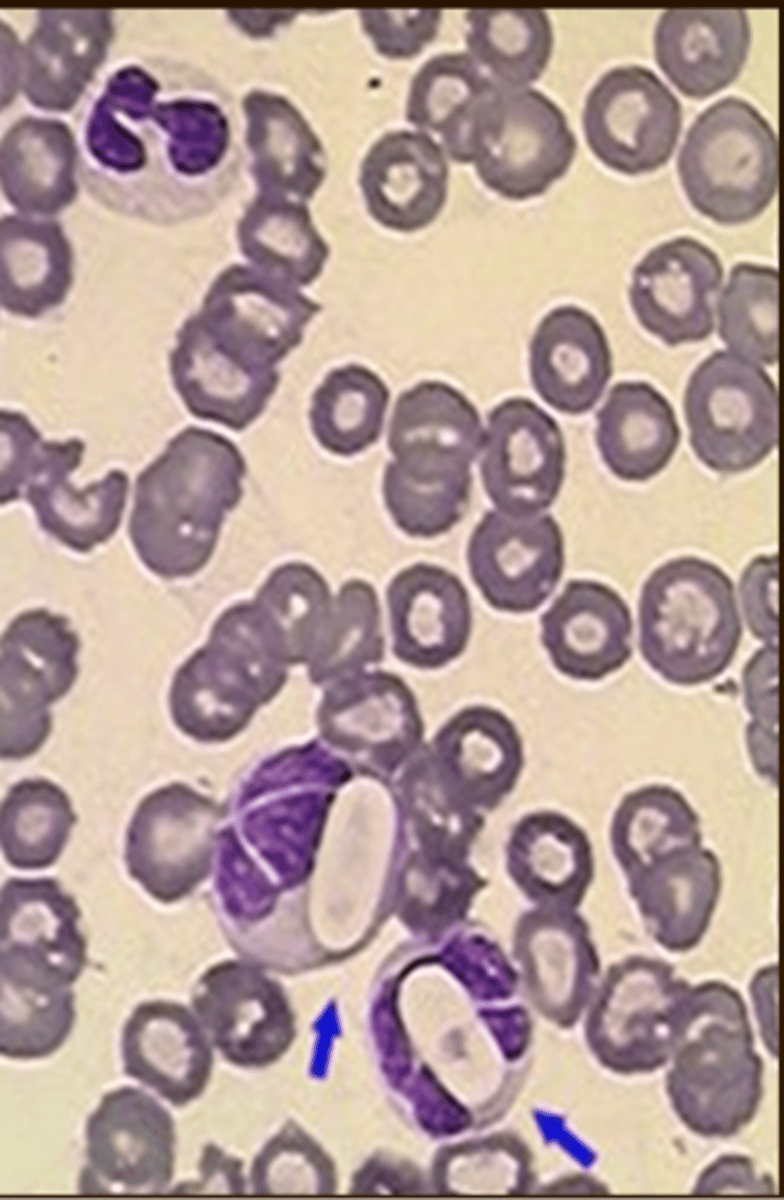
knowt flashcard image
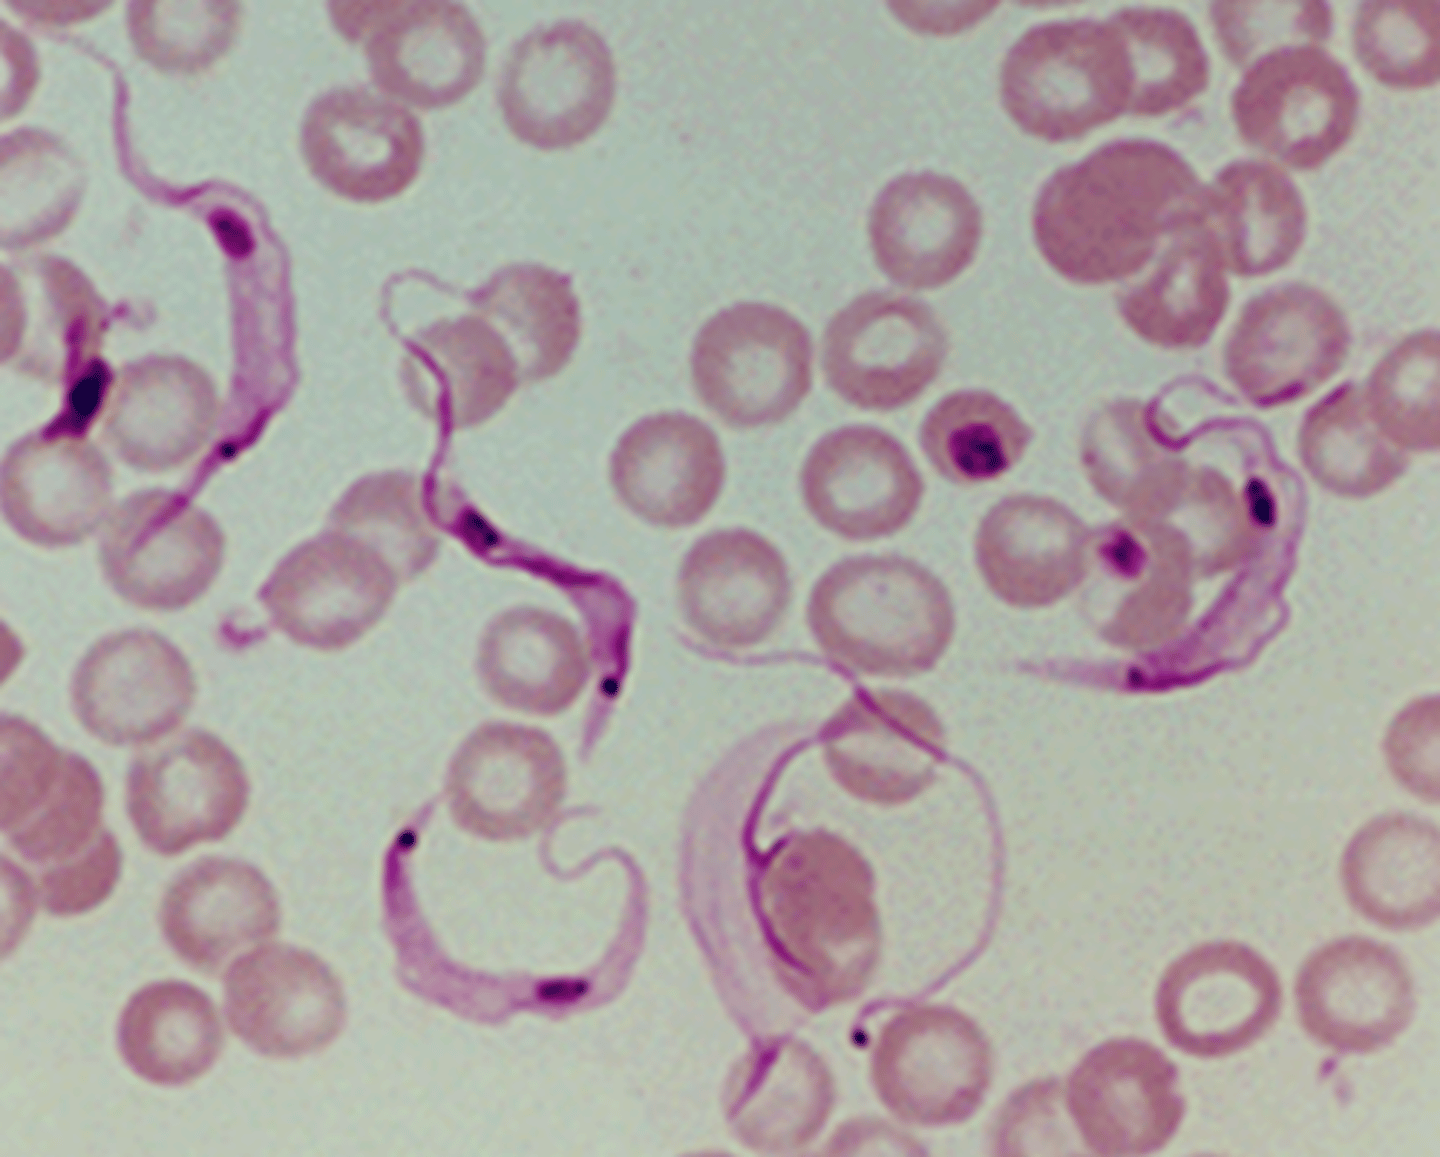
knowt flashcard image
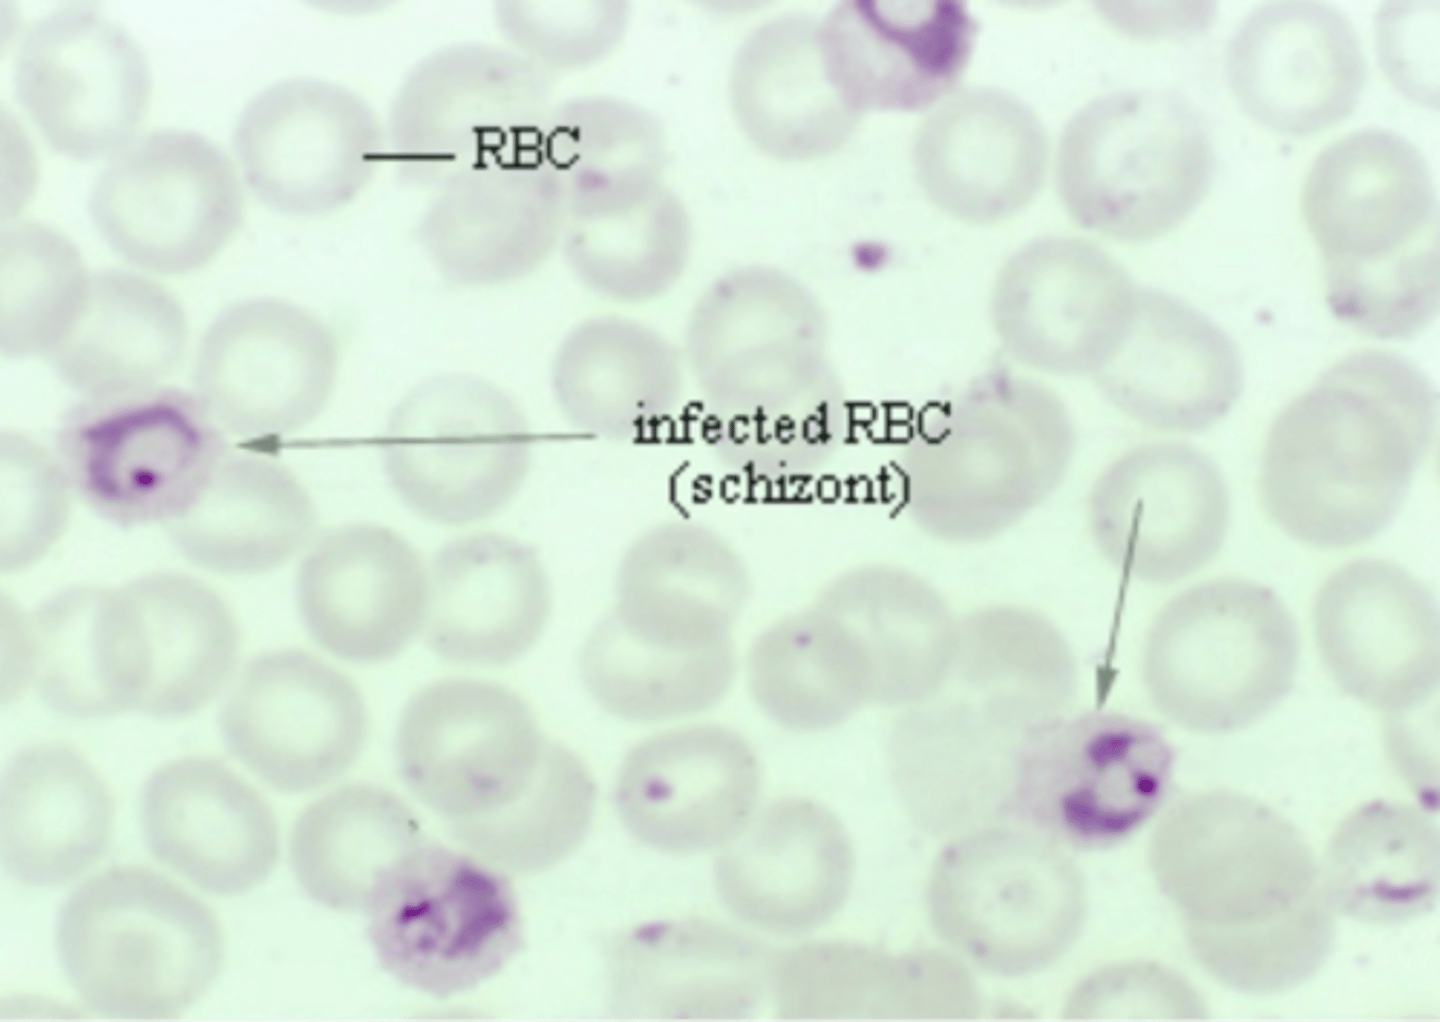
knowt flashcard image
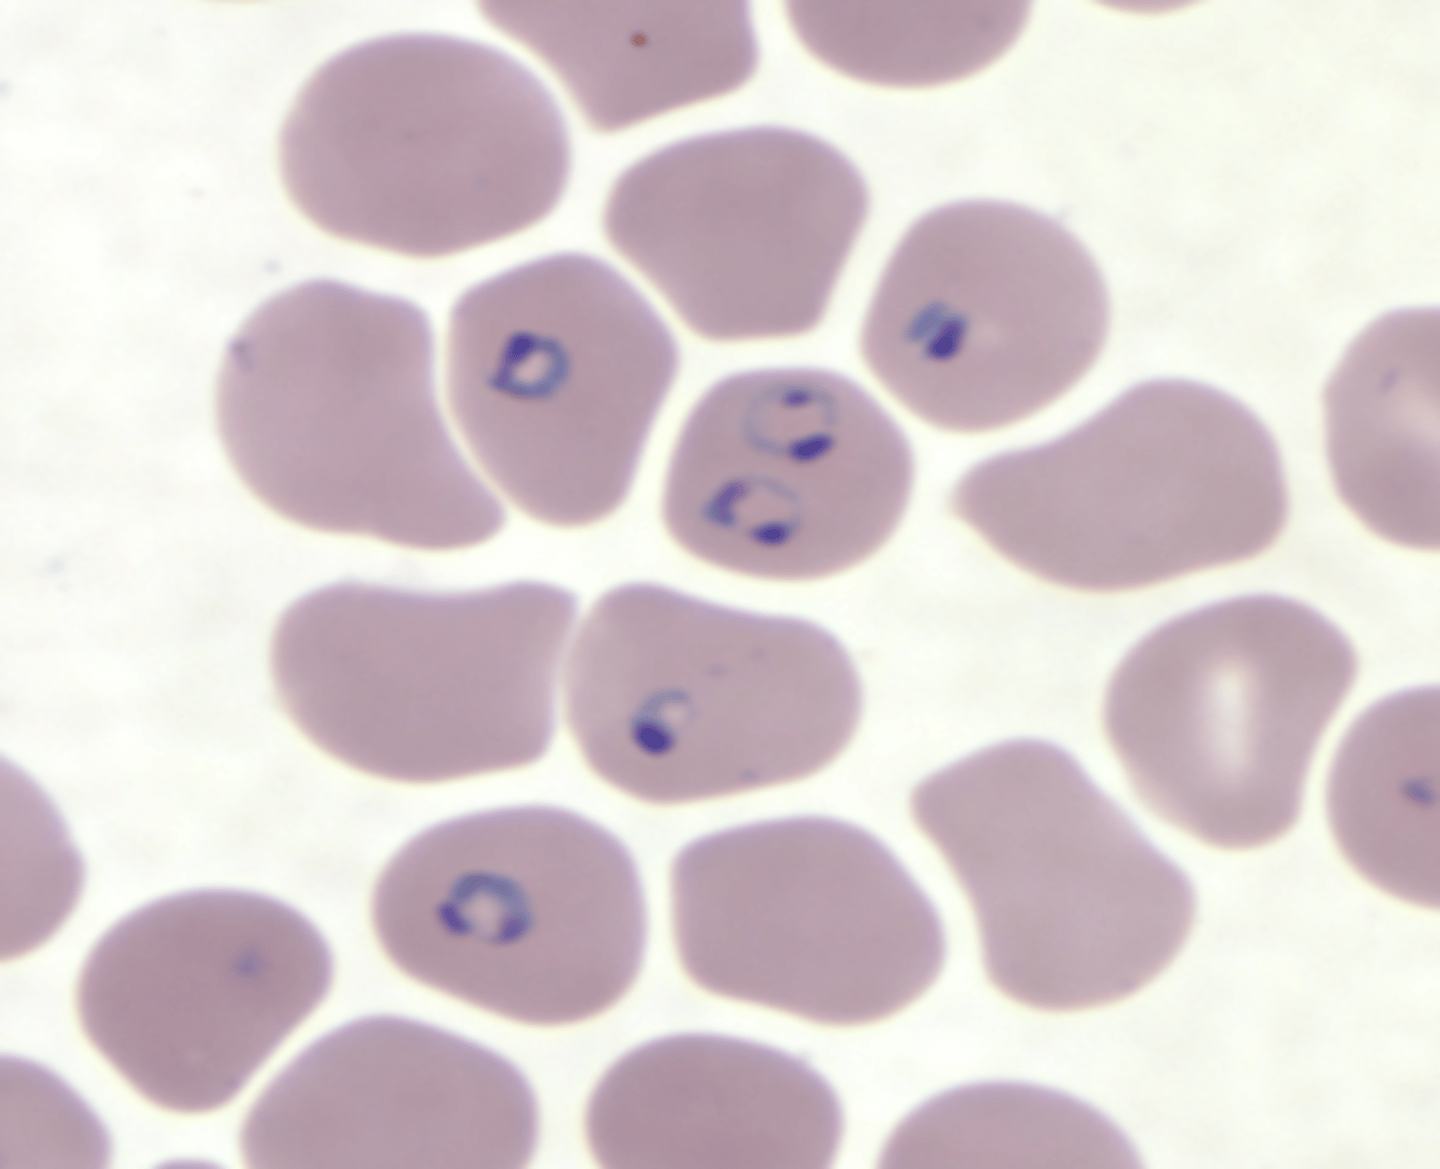
knowt flashcard image
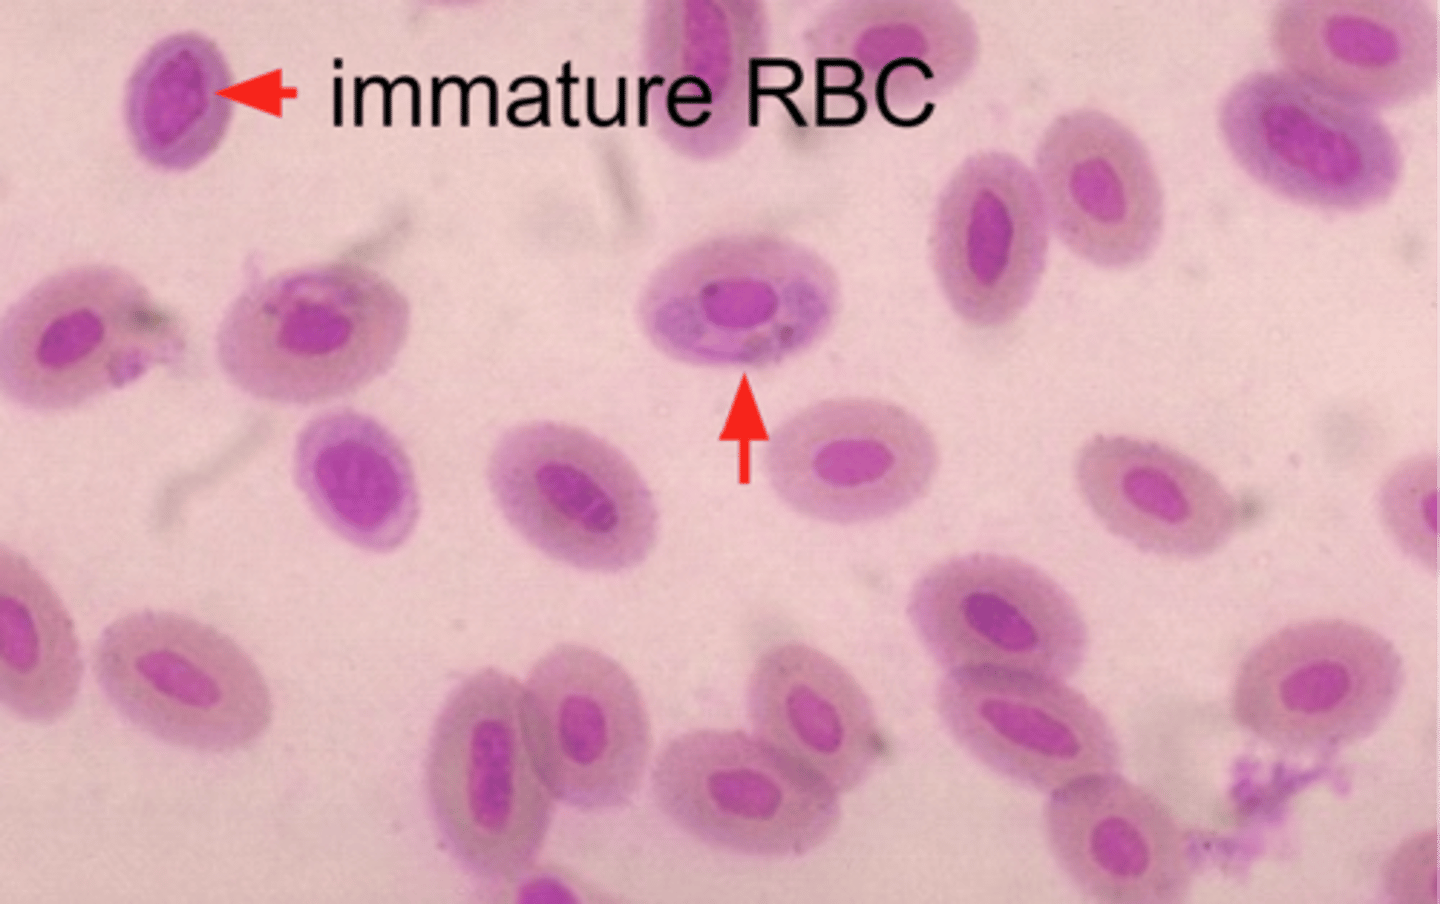
knowt flashcard image
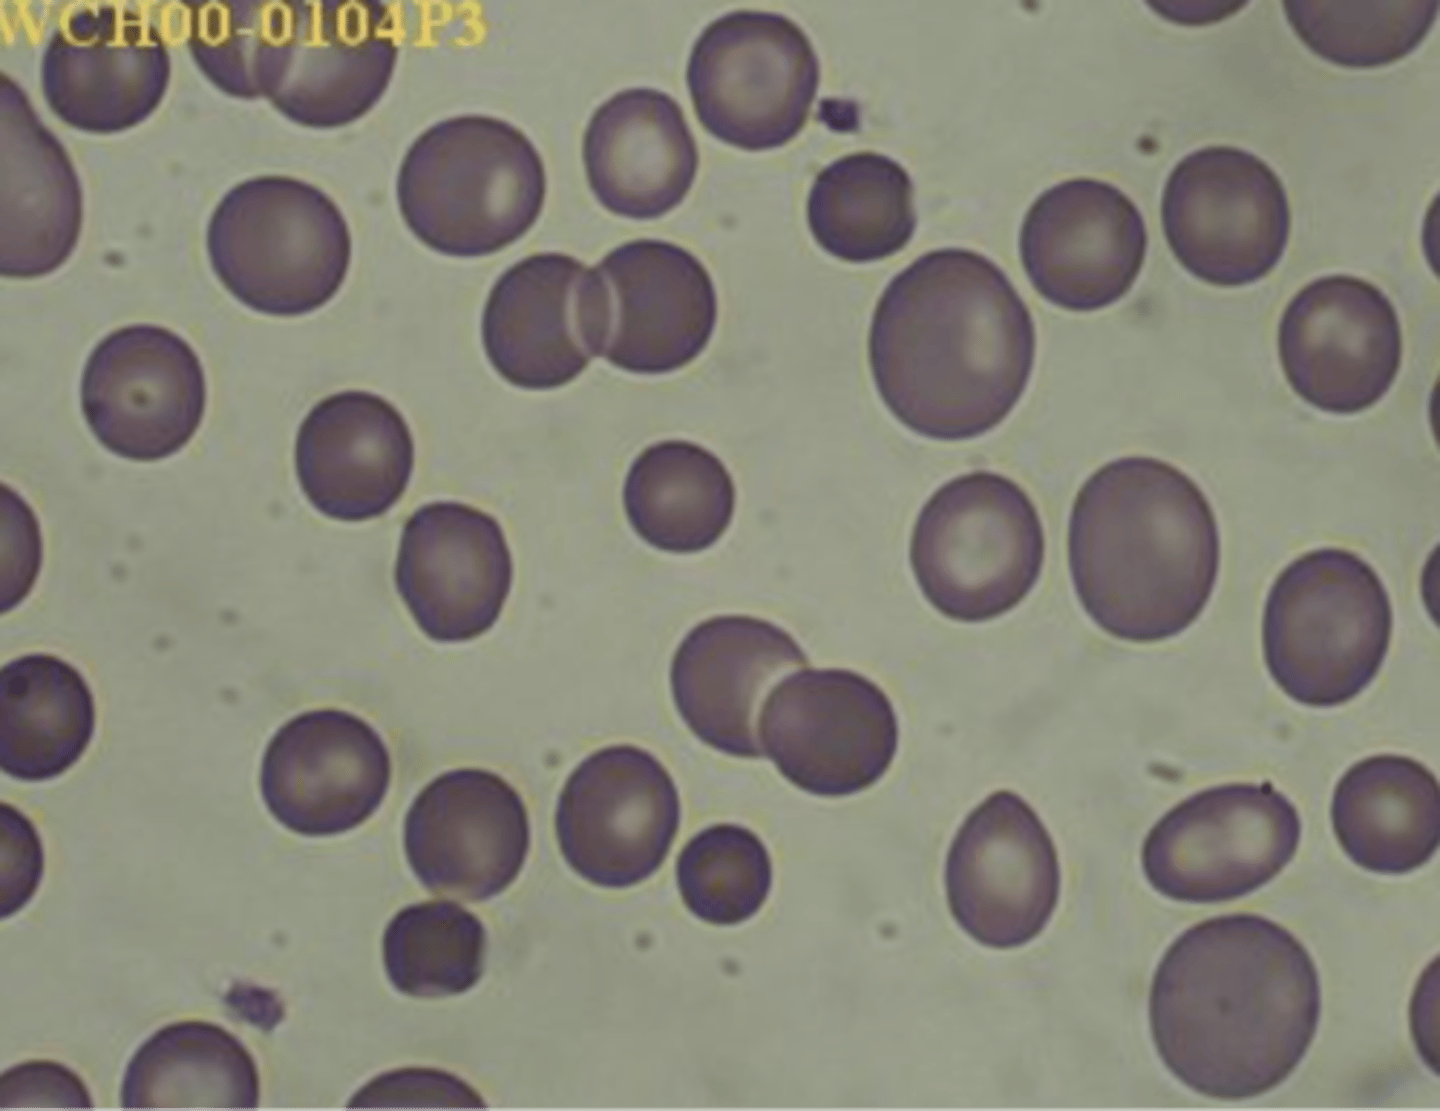
knowt flashcard image
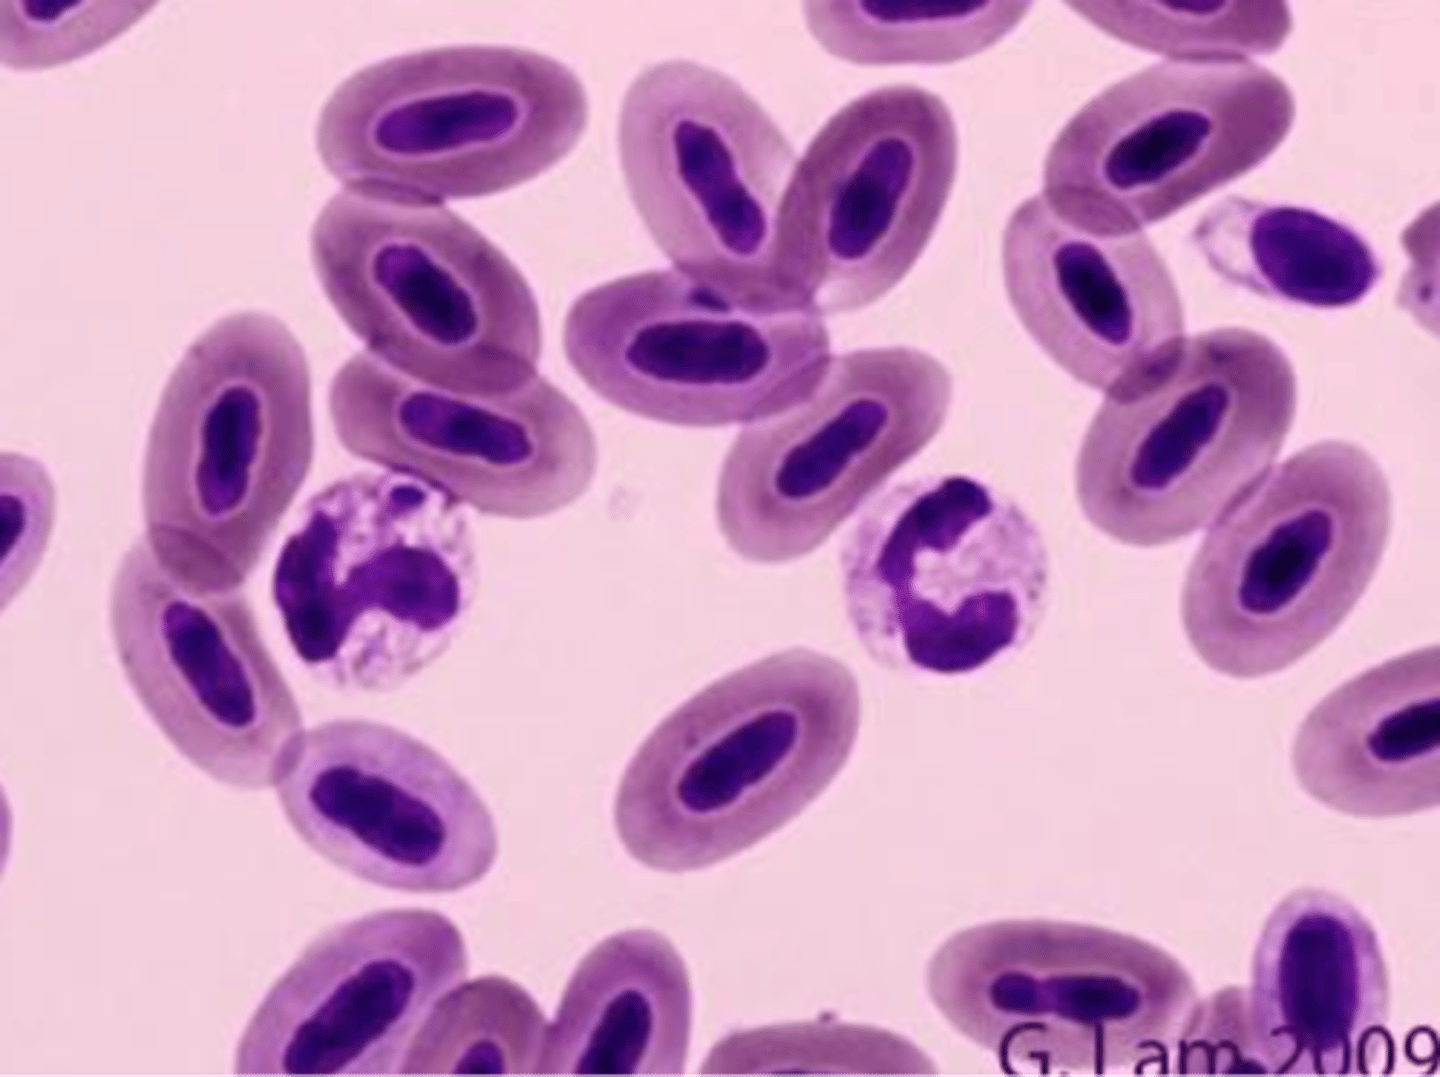
knowt flashcard image
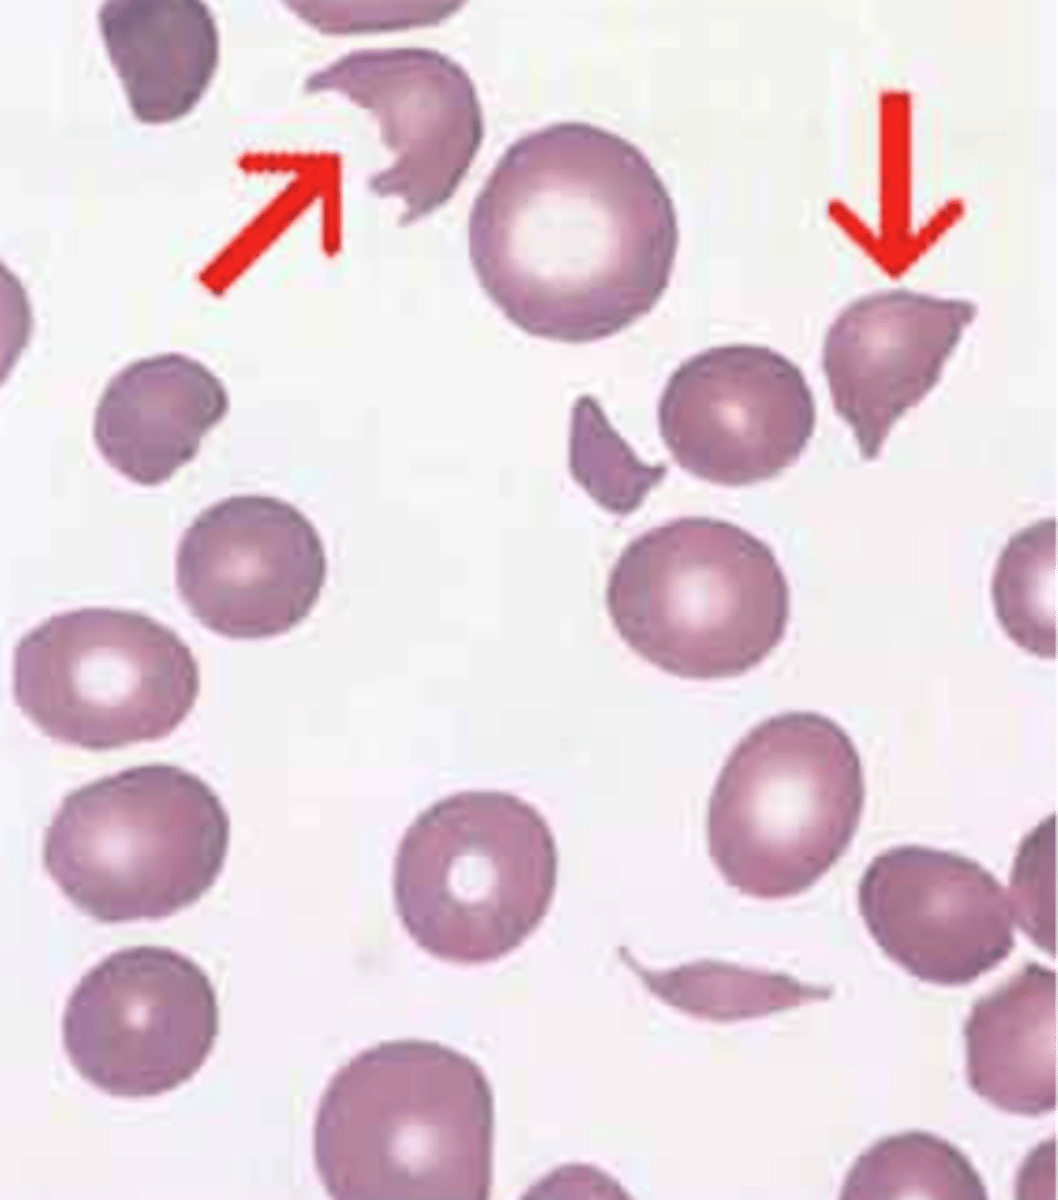
knowt flashcard image
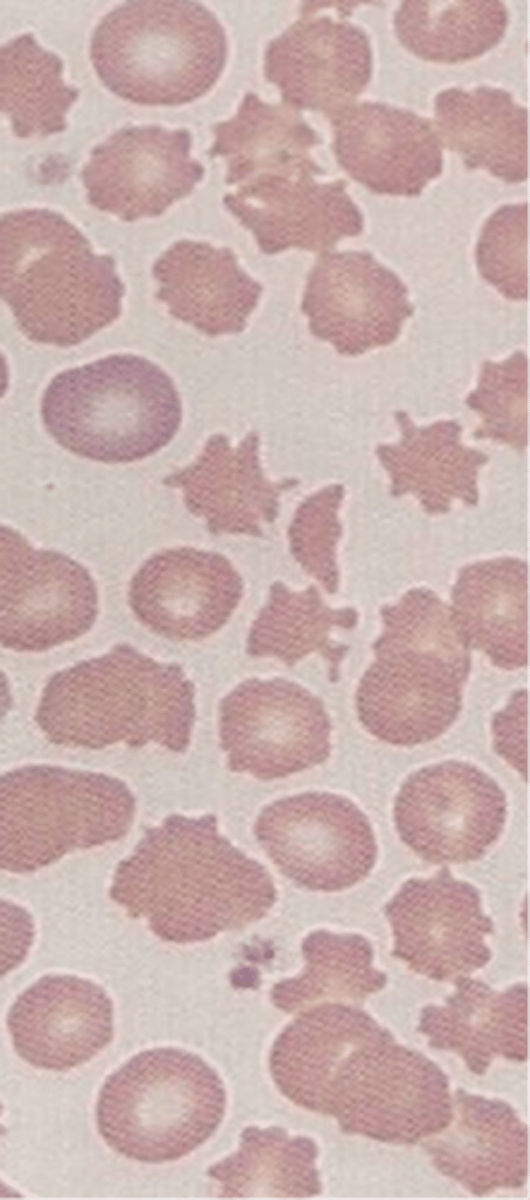
knowt flashcard image
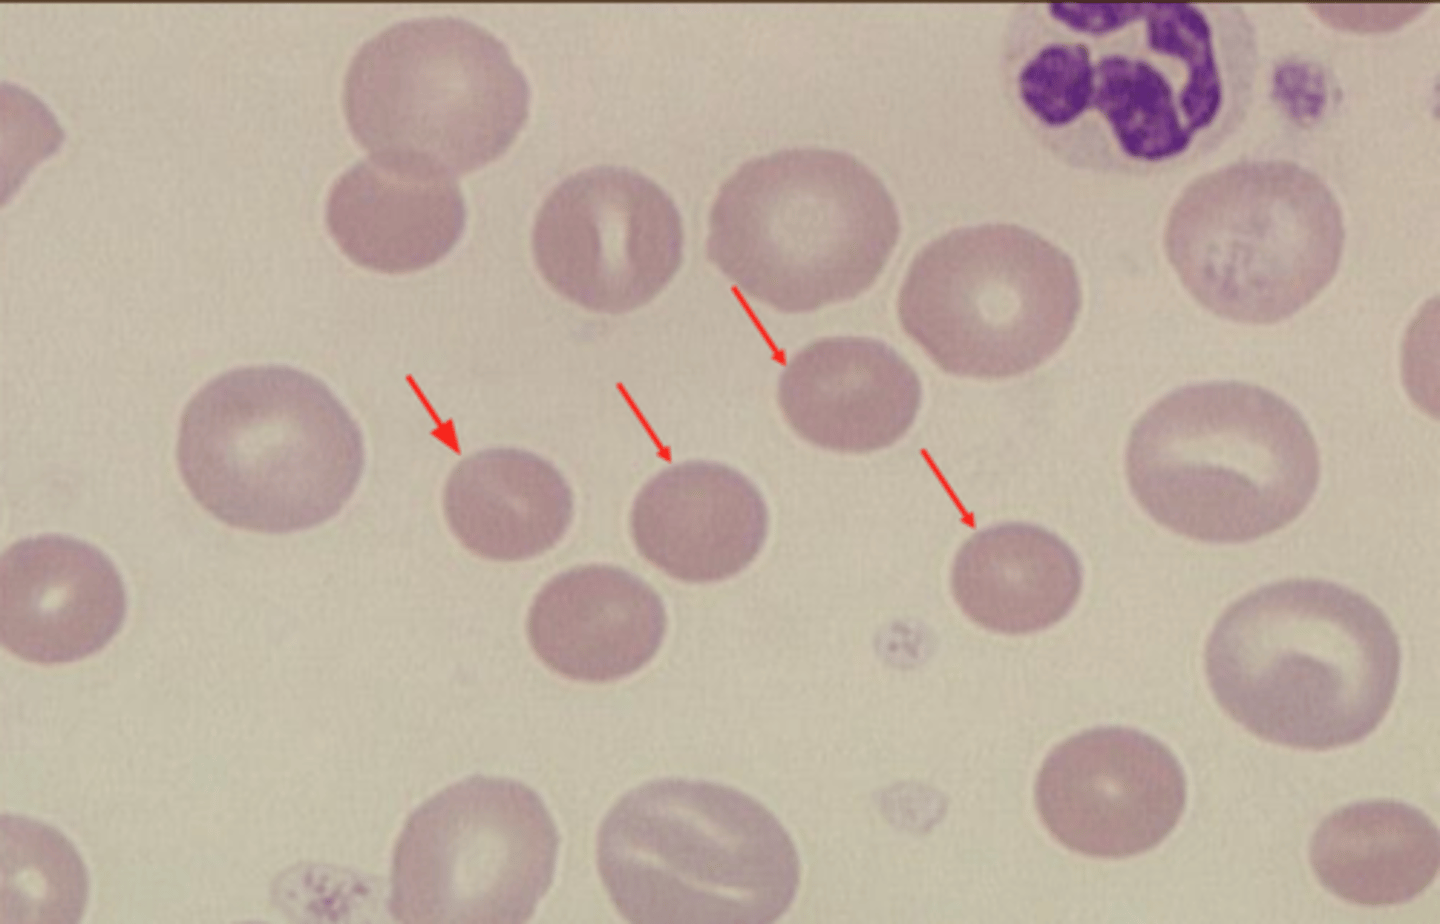
knowt flashcard image
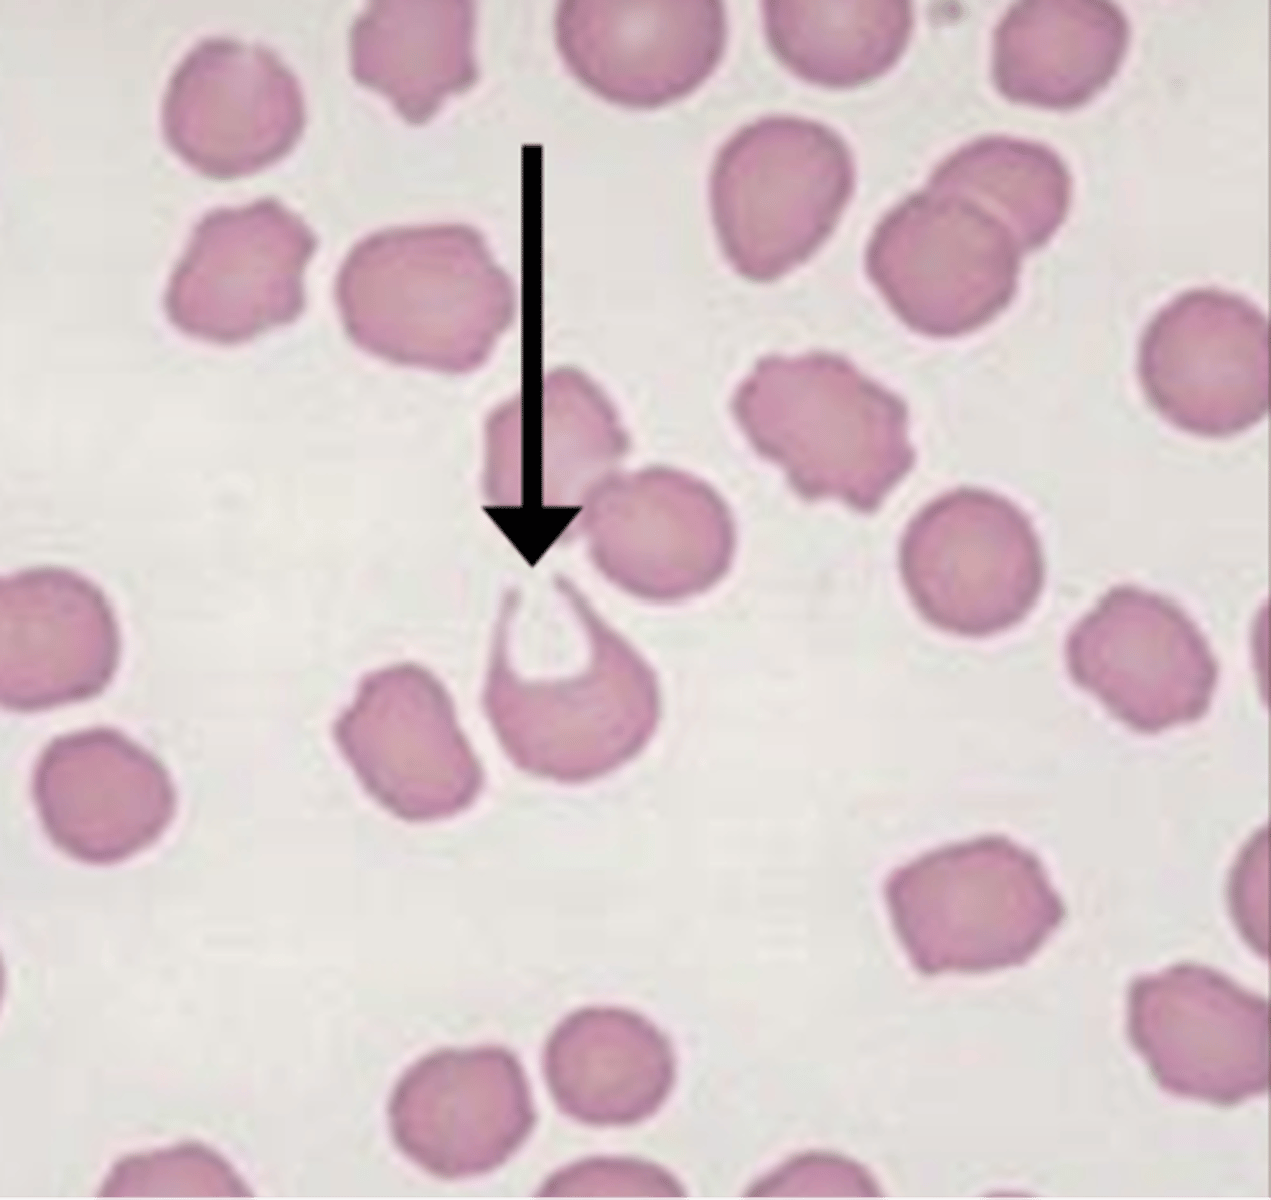
knowt flashcard image
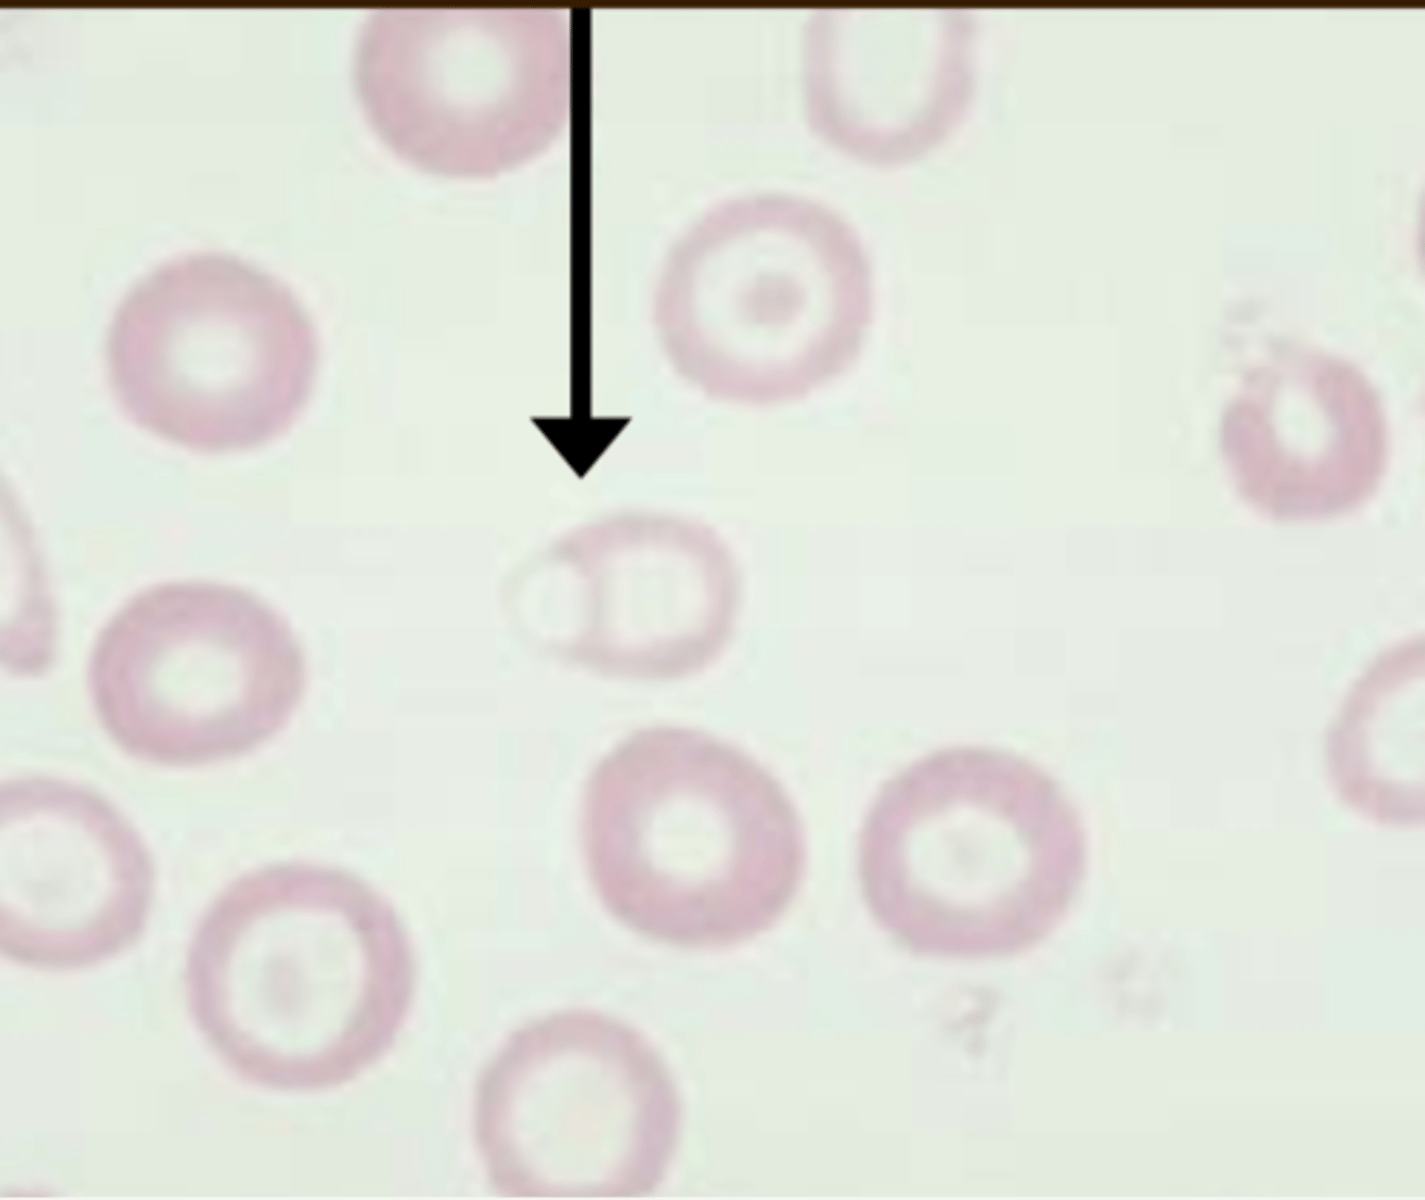
knowt flashcard image
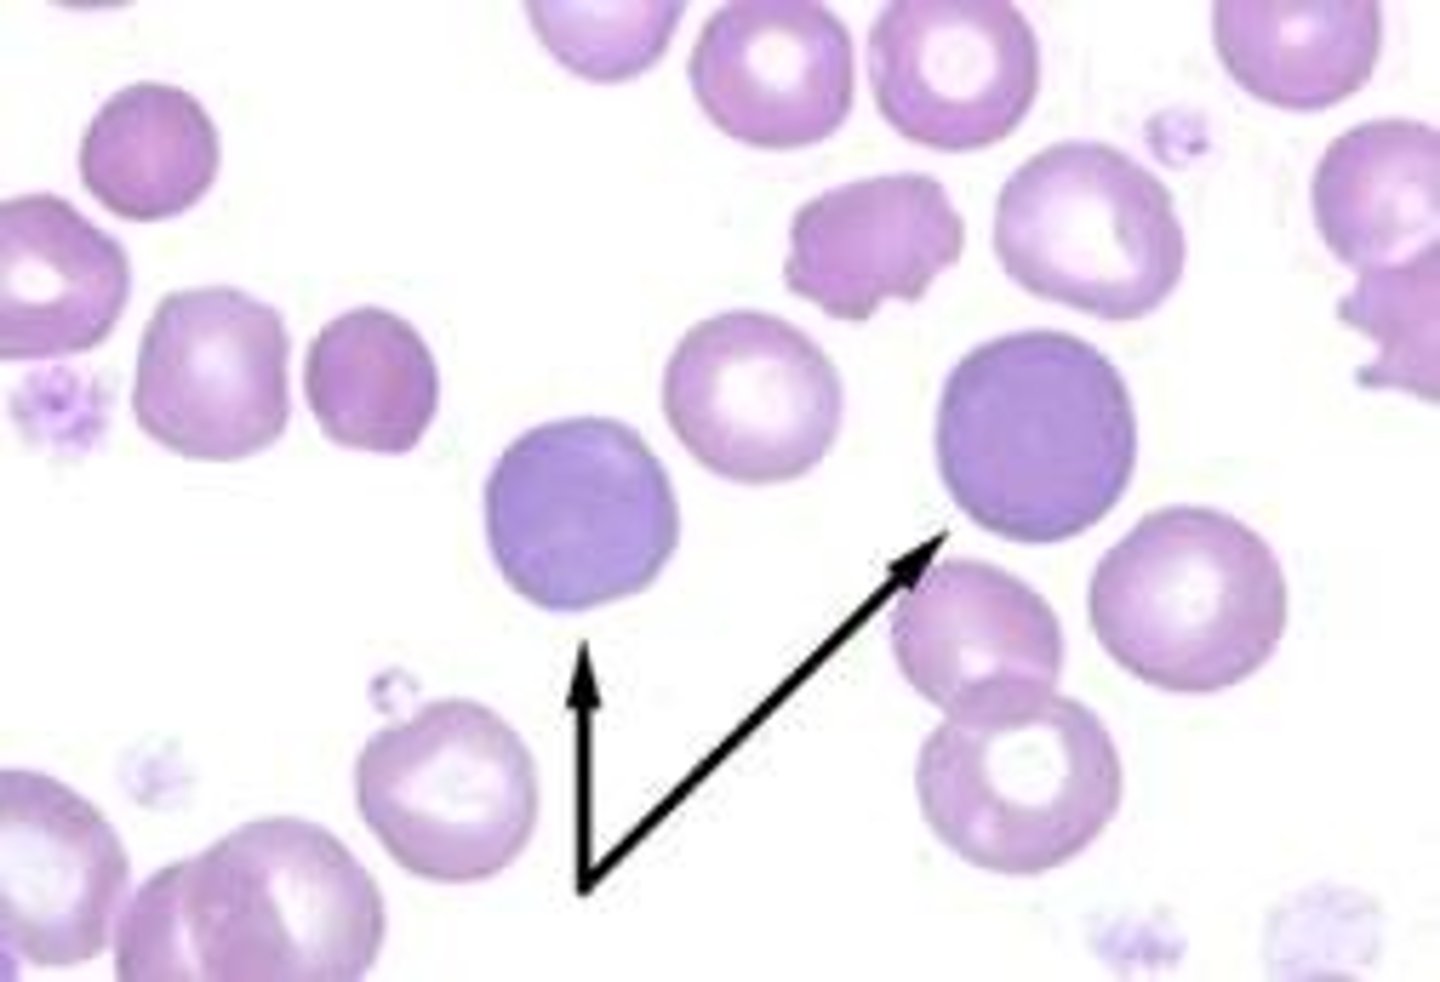
knowt flashcard image

Blood Smears: Key Terms and Definitions in Biology
1/117
There's no tags or description
Looks like no tags are added yet.
Name | Mastery | Learn | Test | Matching | Spaced | Call with Kai |
|---|
No analytics yet
Send a link to your students to track their progress
118 Terms
Basophilic stippling & Nucleated Red Blood Cell

Howell-Jolly body

Spherocytes

Schistocytes

Acanthocytes

Echinocytes

Heinz bodies

Heinz bodies
Codocytes

Agglutination

Rouleaux

Babesia Canis

Babesia gibsoni
Mycoplasma hemofelis

Mycoplasma hemocanis

Cytauxzoon felis
Distemper inclusions
A= segmented neutrophils B= Band neutrophil
Lymphocyte
Eosinophil

Monocyte

Basophil

segmented neutrophil

Basophil

Band neutrophil

Band neutrophil

Top = Monocyte Bottom = segmented neutrophil
Top = segmented neutrophil Bottom = Monocyte
Band neutrophil
Monocyte

Top= Lymphocyte Bottom= Eosinophil
Left = Eosinophil Right = Seg neutrophil

Left= Seg neutrophil Right= Basophil

Mycoplasma haemofelis

Mycoplasma haemofelis

Mycoplasma haemocanis

Mycoplasma haemocanis
Ehrlichia canis
Ehrlichia canis

Ehrlichia canis

Ehrlichia ewingii
Ehrlichia ewingii
Anaplasma platys

Anaplasma platys

Anaplasma platys

Anaplasma phagocytophilum

Anaplasma phagocytophilum

Anaplasma phagocytophilum
Anaplasma marginale
( cow blood )

Anaplasma marginale
Anaplasma marginale
Mycoplasma

Mycoplasma

Mycoplasma

Babesia canis
Babesia canis

Babesia gibsoni
Cytauxzoon felis

Cytauxzoon felis
Leishmania

Leishmania

Leishmania

Hepatozoon

Hepatozoon

Hepatozoon
Trypanosoma
Trypanosoma

Trypanosoma

Plasmodium

Plasmodium
Plasmodium
Avian Plasmodium

Avian Plasmodium

Avian Haemoproteus
Avian Haemoproteus

Avian Leukocytozoon

Avian Leukocytozoon

Avian Atoxoplasma

Avian Atoxoplasma

Anisocytosis
Camelid RBC

Deer RBC (expose to O2)

Sickle Cell Anemia (in humans)

Avian RBCs
Schistocytes
Schistocytes

Acanthocytes

Acanthocytes

Acanthocytes
Echinocytes

Echinocytes

Spherocytes

Spherocytes

Spherocytes
Leptocytes

Stomatocytes

Keratocyte helmet cell
Keratocyte blister cell
Dacryocytes

polychromatophils